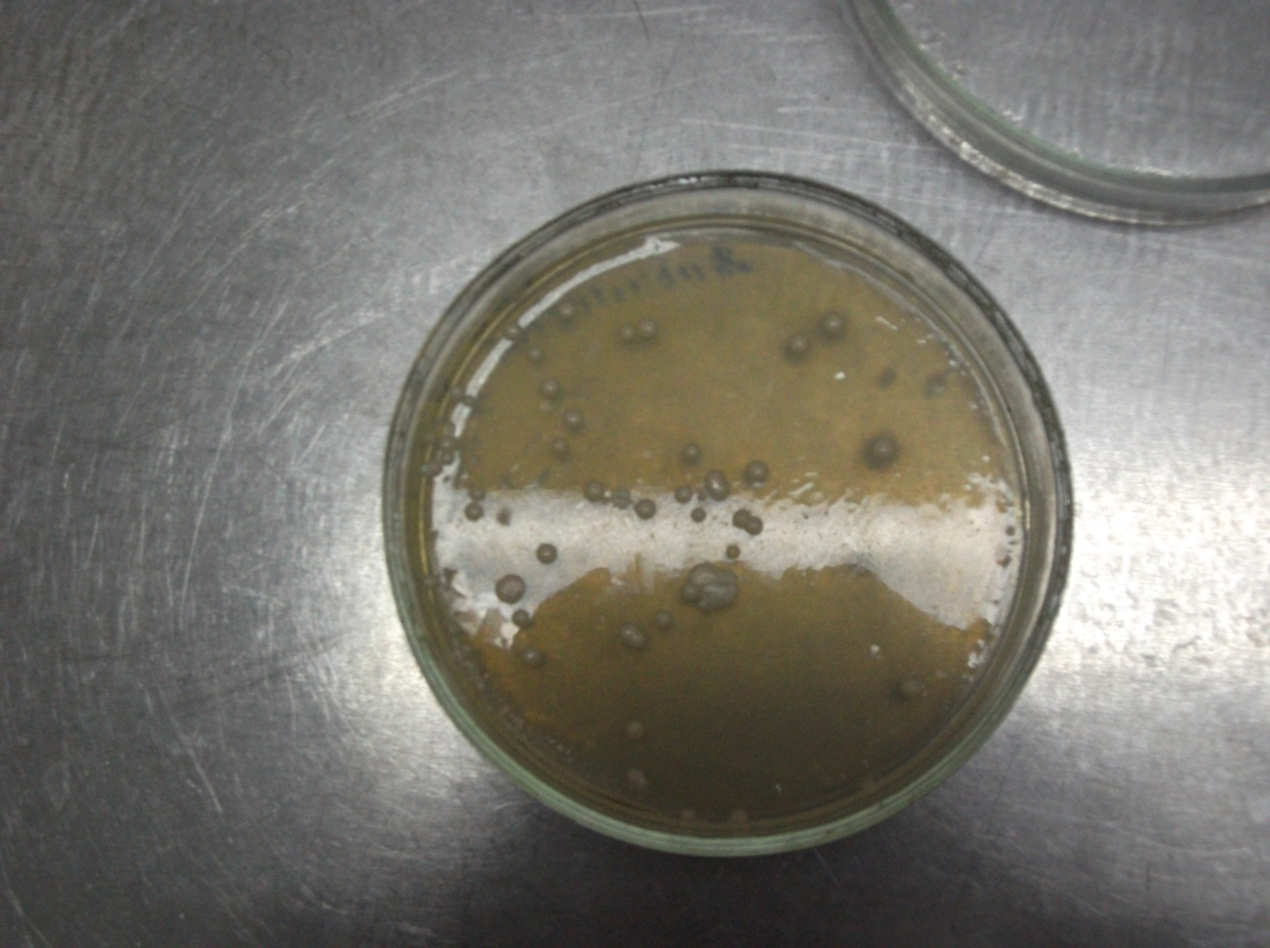

Выделение чистых культур дрожжевых грибов из шишек хмеля
МИНИСТЕРСТВО СЕЛЬСКОГО ХОЗЯЙСТВА РФ
Факультет биотехнологии и стандартизации
Кафедра биологической и химической технологии
Выпускная квалификационная работа
На тему
«Выделение чистых культур дрожжевых грибов из шишек хмеля»
Дипломник: Руководитель и ответственный
за нормоконтроль на соответствие
стандарта, к. к.с.- х.н., ст.преп.
Консультанты:
по экономическим вопросам, к.э.н.
доцент
по охране труда, доцент
по охране окружающей среды, доцент
2009г.
Оглавление
Введение
1 Глава Обзор литературы
1. История применения дрожжей
1.2 Традиционные биохимические процессы, протекающие с применением дрожжей
1.3 Дрожжи в современной биотехнологии
1.4 Систематика дрожжей
2 Общая характеристика хмеля
3 Выделение чистых культур дрожжевых грибов
2 Глава Собственные исследования
Схема направления исследования
2.1 Материалы и методы исследований
2.2 Подготовка питательной среды
2.3 Выделение дрожжей
2.4 Определение видовой принадлежности
2.5 Обсуждение результатов
Глава 3 Экономическая эффективность
Глава 4 Экологическая безопасность
Глава 5 Безопасность жизнедеятельности
Список литературы
Приложения
Введение
Чтобы описать сущность и перспективы развития науки о дрожжах - зимологии, следует в первую очередь дать определение самому объекту этой науки - дрожжевым организмам. Казалось бы, вопрос о том, что такое дрожжи, весьма простой: о дрожжах знает каждый, без них не приготовить кислого теста, вина, пива. И все же дать научное определение дрожжам и четко очертить границы этой группы микроорганизмов становится все труднее по мере расширения наших знаний об этих микроскопических существах, которые включают в царство Mycota.
То, что дрожжи - это грибы, стало понятным уже с начала первых научных описаний этих организмов, сделанных в первой половине прошлого века. Несмотря на одноклеточное строение, внешне более сходное с крупными бактериями, чем с мицелиальными грибами, дрожжи по ультраструктурной организации клетки и способам бесполого и полового размножения сразу же были отнесены к грибам. Однако изучали их, как правило, не микологи, а микробиологи. Причина этого заключается в том, что рост дрожжей на плотных средах очень сходен с бактериальным. Кроме того, человека всегда привлекало свойство дрожжей вызывать спиртовое брожение, и, следовательно, в работе с дрожжами преобладали физиолого-биохимические подходы и методы. Микологи же исторически были связаны с ботаниками, так как долгое время грибы считали низшими растениями, и поэтому в основе их изучения всегда были методы описательной морфологии, а не физиологии. Все это привело к тому, что дрожжи были искусственно оторваны от всех остальных грибов, и хотя им «повезло», что они были объектами работ таких корифеев микробиологии, как Луи Пастер, А. Клюйвер, Г. Надсон, в таксономическом отношении были допущены серьезные ошибки, которые и в наше время исправлять не просто. Под сильным влиянием бродильных свойств некоторых видов дрожжей, эту группу организмов долгое время ограничивали одноклеточными грибами, которые образуют аскоспоры и способны вызывать спиртовое брожение. Все другие грибы с одноклеточной стадией в жизненном цикле называли дрожжеподобными грибами. Только в самом конце XX в. наука о дрожжах полностью вернулась в микологию, а представление об объектах зимологии значительно расширилось.
Сейчас к дрожжам принято относить все те грибы, которые способны вегетативно размножаться в одноклеточной форме, независимо от того, имеют ли они мицелиальную фазу в жизненном цикле и родственны аскомицетовым или базидиомицетовым грибам. Среди дрожжей сейчас рассматривают даже гаплоидные одноклеточные стадии таких грибов, которые образуют макроскопические плодовые тела. При таком понимании дрожжей, их границы с мицелиальными грибами становятся расплывчатыми, а классификация сливается с общей системой грибов.
В связи с новым подходом к трактовке группы дрожжей существенно расширяется и поиск среди них тех биологических способностей, которые могут быть полезными для человека. Наряду с традиционными процессами использования дрожжей в бродильных производствах, в пищевой промышленности и для получения кормовых препаратов на разных источниках сырья, разрабатываются новые пути применения дрожжей для синтеза многих ценных веществ, таких как полисахариды, ферменты и коферменты, микоцины, витамины, органические кислоты, полиолы, каротиноиды и многие другие соединения. Дрожжи используются как векторные системы при разработке биотехнологических процессов производства инсулина, интерферона, гетерологичных белков.
По-новому следует оценивать и роль дрожжей в природных экосистемах. Например, считавшиеся долго безвредными комменсалами многие эпифитные дрожжи, обильно обсеменяющие зеленые части растений, могут оказаться не такими уж «невинными», если учесть, что они представляют собой лишь гаплоидную стадию в жизненном цикле организмов, близко родственных фитопатогенным головневым или ржавчинным грибам. И, наоборот, патогенные для человека дрожжи, вызывающие опасные и трудноизлечимые болезни - кандидоз и криптококкоз - в природе имеют сапротрофную стадию и легко выделяются из мертвых органических субстратов. Из этих примеров видно, что для понимания экологических функций дрожжей необходимо изучение полных жизненных циклов каждого вида. Обнаружены и автохтонные почвенные дрожжи с особыми функциями, важными для образования почвенной структуры. Неисчерпаемы по многообразию и связи дрожжей с животными, особенно с беспозвоночными.
В связи с тем, что дрожжи имеют большое значение в современной биотехнологии, весьма актуальными представляются исследования в направлении поиска штаммов с новыми экономически привлекательными свойствами. Таким образом, целью нашей работы явилось выделение чистой культуры дрожжевых грибов из шишек хмеля.
Для достижения поставленной цели нами решались следующие задачи.
1. Составление методики исследований.
2. Подготовка элективных петельных сред.
3. Выделение чистой культуры дрожжей.
4. Определение видовой принадлежности выделенных дрожжей.
5. Обсуждение полученных нами результатов.
1 Глава. История применения дрожжей
Дрожжи были первыми микроорганизмами, которые человек стал использовать для удовлетворения своих потребностей. Основное свойство дрожжей, которое всегда было привлекательным для человека - это способность к образованию довольно больших количеств спирта из сахара. Первое упоминание о получении спиртных напитков в Египте, так называемой «бузы», представляющей собой разновидность пива, относится к 6000 г. до н. э. Этот напиток получали в результате сбраживания пасты, полученной при раздавливании и растирании проросшего ячменя. Приготовление бузы можно считать рождением современного пивоварения. Из Египта технология пивоварения была завезена в Грецию, а оттуда в Древний Рим. В этих же странах активно развивалось виноделие. Крепкие спиртные напитки, полученные перегонкой бражки, по-видимому, были впервые получены в Китае около 1000 г. до н. э. В Европу процесс производства спирта был завезен значительно позже. Известно, что получение виски было налажено в Ирландии в XII в. Сейчас промышленное производство спиртных напитков существует в большинстве стран мира и представляет собой крупную отрасль промышленности. (Бабьева И.П., Голубев В. И.)
Другая группа процессов, в которых издавна используются дрожжи, также связана с их способностью к спиртовому брожению: образование углекислого газа под действием дрожжей - важнейший этап в приготовлении хлеба, приводящий к заквашиванию теста. Этот процесс также очень древний. Уже к 1200 г. до н. э. в Египте была хорошо известна разница между хлебом из кислого и пресного теста, а также польза от применения вчерашнего теста для заквашивания свежего. (Бабьева И.П., Голубев В. И.)
1.2 Традиционные биохимические процессы, протекающие с применением дрожжей
Виноделие, пивоварение и хлебопечение существуют уже несколько тысячелетий. Естественно, что за это время были отселекционированы сотни видов заквасок, которые используются для приготовления самых различных сортов вина и пива. Однако лишь в начале XIX в. были высказаны предположения, что за спиртовое брожение, вызываемое этими заквасками, ответственны присутствующие в них дрожжи. Увиденные впервые в 1680 г. Антони ван Левенгуком. Эти дрожжи были описаны в 1837 г. Мейеном, который дал им название Saccharomyces. Окончательным доказательством роли дрожжей в сбраживании сахаров считается работа Пастера, опубликованная им в 1866 г. К концу ХIХ в. стало известно, что сахаромицеты, выделенные из различных заквасок и различных сортов вина и пива, различаются по физиологическим свойствам, например, по способности к сбраживанию различных сахаров. В дальнейшем на основании таких физиологических различий в роде Saccharomyces было описано несколько десятков видов. Однако, в последние годы методами молекулярной и генетической таксономии было показано, что большинство этих «видов» на самом деле представляют собой различные физиологические расы нескольких близких биологических видов, главным образом Saccharomyces cerevisiae. Это такие «виды», как, например, Saccharomyces vini, Saccharomyces ellipsoides, Saccharomyces oviformis, Saccharomyces cheresiensis, Saccharomyces chevalieri и десятки других, которые сейчас переведены в разряд синонимов Saccharomyces cerevisiae. Большинство этих «видов» - это отселекционированные веками расы - такой же продукт человеческой деятельности, как сорта культурных растений. В природе их найти иногда просто невозможно. Однако, недавно Г.И.Наумов обнаружил, что дикие популяции Saccharomyces cerevisiae распространены на Дальнем Востоке в сокотечениях дуба. Он предположил, что Дальний Восток - центр видообразования этих дрожжей. Кроме Saccharomyces cerevisiae в природных местообитаниях обнаружены еще несколько очень близких видов-двойников: Saccharomyces bayanus, Saccharomyces paradoxus и Saccharomyces cariocanus, Saccharomyces kudriavzevii, Saccharomyces mikatae, а также их межвидовые гибриды. (http://soil.msu.ru/soilyeasts/genera/Naumov.htm).
Кроме вина и пива, ставшими наиболее популярными, в мире производится множество разнообразных традиционных алкогольных напитков: сакэ на Востоке, текила в Южной Америке, помбе в Африке и т.д. Они различаются по типу исходного сырья, способами осахаривания полисахаридов, видами добавок. В некоторых случаях для сбраживания используются виды дрожжей, отличные от Saccharomyces cerevisiae. При производстве рома, например, применяются дрожжи из рода Schizosaccharomyces. (Соловьёва О.И.).
Дрожжи используются также при изготовлении множества других традиционных пищевых продуктов. Например, специальные расы дрожжей входят в состав заквасок, использующихся для приготовления кефира. Дрожжи применяются в сыроварении при получении некоторых сортов сыра. В Восточной Азии широко распространены многочисленные закваски для получения разнообразных традиционных соусов, в состав которых входят специфические виды дрожжей, не встречающиеся в других местообитаниях. В быту большую популярность получил «чайный гриб» - специфическая бактериально-дрожжевая ассоциация, с помощью которой получают легкий, освежающий напиток. ( Коновалов С.А.).
На протяжении нескольких тысяч лет человечество совершенствовало технологии изготовления вина, пива и хлеба и других продуктов, получаемых с помощью дрожжей, доводя их до уровня искусства и получая все более изысканные продукты. Новый этап в развитии бродильных процессов начался после работ Пастера, Коха и других корифеев микробиологии, которые ввели в практику метод чистых культур. Тем не менее, до конца ХIХ в. дрожжи применялись лишь в виноделии, пивоварении и хлебопечении. Двадцатый век с его безудержным развитием промышленности резко расширил и области применения дрожжей. Они стали выращиваться в больших масштабах в качестве источника белка и витаминов для сельскохозяйственных животных. Дрожжи - основной источник технического этанола. С помощью дрожжей сейчас получают большой спектр соединений, использующихся в разных областях человеческой деятельности. К ним относятся витамины, различные полисахариды, липиды, которые могут служить заменителями растительных масел, разнообразные ферменты, используемые в пищевой промышленности. Развитие генетической инженерии позволило использовать легко культивируемые дрожжи для получения многих полезных веществ животной и растительной природы, например инсулина.( Жвирблянская А.Ю., Исаева В.С.).
В основе получения вина лежит сбраживание фруктозы и глюкозы виноградного сока с образованием этилового спирта. Собранный виноград давят и получают так называемое виноградное сусло, или муст, в котором содержится 10-25% сахара. При производстве красного вина кожица и косточки винограда остаются в соке в течение всего процесса брожения, тогда как для приготовления белых вин их удаляют после раздавливания ягод и сбраживается только сок. В традиционных процессах приготовления вина сбраживание муста ведется с помощью дрожжей, присутствующих на винограде. При этом в брожении участвует множество видов дрожжей, сменяющих друг друга, такие как Hanseniaspora, Brettanomyces, Saccharomyces. В современном виноделии для сбраживания в основном используют чистые культуры специальных рас сахаромицетов. При этом присутствующие в сусле «дикие» дрожжи сначала убивают, обычно пропуская через муст двуокись серы. После окончания брожения молодое вино необходимо осветлить и дать ему созреть. Эти процессы для высококачественных вин могут занимать несколько лет. В процессе созревания вина происходит рост бактерий, которые удаляют из него яблочную кислоту, а также различные биохимические изменения, которые улучшают вкусовые качества вина. (Г.Г. Валуйко и В.Т. Косюры).
При производстве некоторых сортов вин в качестве исходного сырья используется не виноградный сок, а уже готовое вино. Такое, так называемое вторичное виноделие, включает процессы дображивания и модификации вин с использованием специальных рас дрожжей. К наиболее известным продуктам вторичного виноделия относятся шампанские вина. Шампанское получают из смеси вин (купажа), в которую добавляют сахар и дрожжи, после чего выдерживают в замкнутом объеме для вторичного брожения (шампанизации). Традиционные процессы шампанизации проводятся в бутылках, на крупных заводах - в больших емкостях. При шампанизации происходит растворение и химическое связывание образующейся углекислоты, которая при открывании бутылки в результате перепада давления освобождается и придает вину неповторимую игристость. (Ж. Риберо-Гайон, Э. Пейно, П. Риберо-Гайон, П. Сюдро.)
Дрожжи вносят в производство вина двойной вклад: они ответственны за образования этанола в напитке, а также за накопление в нем множества вторичных соединений, от которых зависит его вкус и аромат. Такие соединения называются органолептическими. Часть из них образуется непосредственно в ходе брожения, часть - при химических превращениях компонентов вина в ходе его созревания. В винах обнаружены сотни органолептических соединений. Многие из них присутствуют в очень малых количествах и с трудом поддаются идентификации. Еще сложнее определить вклад всех этих соединений в окончательный букет вина, поскольку для каждого вещества характерна своя концентрация, при которой его присутствие можно уловить с помощью обоняния (так называемый порог запаха). (Фертман Г.И., Шойхет М.И.).
Технология приготовления пива включает несколько этапов. Пиво производят из зерна, которое в отличие от винограда содержит в основном крахмал, плохо усваиваемый дрожжами. Поэтому перед сбраживанием этот крахмал необходимо осахарить (гидролизовать). Традиционно в различных странах для производства пива использовали различные виды зерновых: в Европе - ячмень, в Азии - рис, в Америке - кукурузу. При осахаривании ячменя обычно пользуются амилазами самого ячменя, которые образуются в большом количестве при прорастании зерна. Для гидролиза рисового крахмала на Востоке традиционно используют некоторые штаммы мицелиальных грибов (Mucor, Aspergillus). Проросший и высушенный ячмень (так называемый солод) затем высушивают в печи. При этом в результате карамелизации сахаров образуются окрашенные соединения, которые придают пиву характерный цвет. Высушенный солод размалывают, смешивают с водой и варят, в результате чего получается так называемое пивное сусло. В результате всех этих процессов часть крахмала исходного зерна гидролизуется до мальтозы, глюкозы и других сахаров, другая часть, фракция декстринов, не расщепляется и поэтому не утилизируется дрожжами и остается без изменений в течение всего последующего процесса брожения. Концентрация декстринов обусловливает плотность пива (светлое или темное). После осахаривания зерно высушивают, размалывают, кипятят, фильтруют. В процессе варки сусла в него обычно добавляют хмель, придающий пиву характерный горьковатый привкус. Полученное пивное сусло сбраживают чистыми культурами дрожжей Saccharomyces cerevisiae. (Г.И. Фертман М.И., Шойлет М.)
В пивоварении различают два типа брожения: верховое (теплое) и низовое (холодное). Вызывающие их дрожжи различаются рядом свойств и ранее рассматривались как различные виды: верховые Saccharomyces cerevisiae и низовое Saccharomyces carlsbergensis. Дрожжи низового брожения функционируют при температуре 6-10°C, в то время как верховое брожение протекает при 14-25°C. В конце брожения низовые дрожжи оседают на дно сосуда, образуя плотный осадок, а верховые дрожжи всплывают на поверхность, образуя так называемую «шапку». Подъем дрожжей верхового брожения на поверхность обусловлен более интенсивным брожением, при котором образуются пузырьки углекислого газа, поднимающие дрожжевые клетки. (Довгань В.Н. ).
Важное технологическое свойство дрожжей, используемых в пивоварении - так называемая флоккуляционная способность. Флоккуляция - слипание клеток друг с другом на заключительных стадиях брожения, в результате чего образуются хлопья, быстро оседающие на дно сосуда. От флоккуляционной способности дрожжей в значительной степени зависят степень сбраживания сусла, осветление пива и количество собранных дрожжей в конце брожения. Для максимального превращения сахара в этанол необходимо, чтобы дрожжи оставались суспендированными в бродящей жидкости. С другой стороны, флоккуляция дрожжей после того, как брожение закончилось или достигло желаемой стадии, очень облегчает удаление дрожжей из напитка. Другими словами, дрожжи должны флоккулировать только на определенной стадии брожения. Хотя важность процесса флоккуляции в изготовлении алкогольных напитков была оценена уже более ста лет назад, физиологический механизм этого явления был изучен лишь в последние десятилетия. В слипании клеток участвуют присутствующие в растворе ионы двухвалентного кальция, взаимодействующие с карбоксильными и фосфодиэфирными группами на поверхности клеточных стенок дрожжей. (Главачек Ф., Лхотский А.).
Все дрожжи, которые используются в хлебопечении, относятся к виду Saccharomyces cerevisiae и исторически происходят от штаммов пивных дрожжей. Мука обычно почти не содержит свободных сахаров, которые могут сбраживаться дрожжами. В низкосортной муке могут присутствовать ферменты, расщепляющие крахмал, однако в высокоочищенных сортах муки эти ферменты разрушены, и для заквашивания теста в муку приходится добавлять сахар. При брожении происходит интенсивное выделение СО>2>, которая задерживается в тесте, заставляя его подниматься. Образующийся спирт удаляется в процессе выпечки.( Щербатенко В. В.).
Раньше дрожжи для хлебопечения получали с пивоварен. В конце ХIХ в. развилась целая отрасль по производству прессованных или сухих пекарских дрожжей. Современное производство пекарских дрожжей имеет ряд существенных особенностей по сравнению с бродильной промышленностью. Основная цель такого производства - получение дрожжей, которые с высокой скоростью вырабатывают в тесте углекислый газ за счет брожения в анаэробных условиях. Однако производить их надо при хорошей аэрации, чтобы добиться большего выхода дрожжевой биомассы (эффект Пастера). Полученные дрожжи должны не только обладать высокой бродильной активностью в тесте, но и хорошо храниться, не теряя своих качеств в замороженном или высушенном состоянии. Пекарские дрожжи выращивают в больших сосудах при интенсивном перемешивании и аэрации. При этом питательная среда, основой которой обычно служит меласса, подается постепенно, или порциями. Если добавить сразу много сахара, то метаболизм дрожжей переключится на бродильный (эффект Кребтри) и выход биомассы уменьшится. По завершении роста дрожжи концентрируют центрифугированием и фильтруют. Образующийся на фильтре осадок можно превращать в брикеты прессованных дрожжей. Сухие дрожжи получают высушиванием массы в специальных распылительных сушилках. (http://soil.msu.ru/soilyeasts/pics/PasteurEffect.htm).
1.3 Дрожжи в современной биотехнологии
Дрожжи как источник белка
Использование микробной биомассы для обогащения кормов белком и незаменимыми аминокислотами в условиях интенсивного животноводства - одна из важных проблем будущего, так как человечество развивается таким образом, что оно вряд ли сможет обеспечить себя пищей традиционными методами. Выращивание микроорганизмов не зависит от климатических и погодных условий, не требует посевных площадей, поддается автоматизации. Дрожжи - одна из наиболее перспективных групп микроорганизмов для получения белковых кормовых добавок. Содержание белка в клетках некоторых штаммов дрожжей составляет от половины до 2/3 сухой массы, на долю незаменимых аминокислот приходится до 10% (в белках сои, богатых лизином, его содержится не многим более 6%).( Коновалов С.А.).
Впервые дрожжи стали рассматривать как источник питания в годы первой мировой войны в Германии, где их использовали в качестве добавки при изготовлении колбас. В первой половине XX в. возникла новая отрасль промышленности - производство белка одноклеточных организмов. В нашей стране производство кормовых дрожжей было начато в 30-х годах. Отходы сельского хозяйства, такие как солома, кукурузные кочерыжки, опилки, подвергали гидролизу серной кислотой, полученные гидролизаты нейтрализовали и использовали для выращивания дрожжей. Особенно привлекательным в этом производстве является использование возобновляемого сырья, особенно древесины, запасы которой в нашей стране пока достаточно велики. В большинстве этих отходов основным компонентом является целлюлоза, и в гидролизатах будет преобладать глюкоза, усваиваемая всеми без исключения видами дрожжей. Поэтому на гидролизатах можно выращивать самые разнообразные дрожжи, удовлетворяющие технологическим требованиям. В гидролизатах древесины присутствует также большое количество ксилозы, поэтому здесь желательно использование видов, утилизирующих пентозы. В то же время, транспорт сырья на гидролизные заводы оказывается дорогостоящим, поэтому в большинстве стран существуют только локальные мелкие производства кормовых дрожжей, что экологически и экономически более выгодно.
Первый в мире крупный завод кормовых дрожжей мощностью 70 000 т. в год. был пущен в 1973 г. в СССР. В качестве сырья на нем использовали выделенные из нефти н-алканы и несколько видов дрожжей, способных к быстрому росту на углеводородах: Candida maltosa, Candida guilliermondii, Candida lipolytica. В дальнейшем именно отходы от переработки нефти служили главным сырьем для производства дрожжевого белка, которое быстро росло и к середине 80-х гг. превысило 1 млн. т. в год, причем в СССР кормового белка получали вдвое больше, чем во всех остальных странах мира, вместе взятых. Этому способствовала организация большой научно-исследовательской работы. Были подробно изучены специфические особенности окисления и ассимиляции углеводородов, кинетические параметры роста, разработана технология их культивирования в крупных ферментерах объемом в сотни кубических метров. Однако в последующем масштабы производства дрожжевого белка на углеводородах нефти резко сократились. Это произошло как в результате экономического кризиса 90-х гг., так и из-за целого ряда специфических проблем, с которыми связано это производство. Одна из них - необходимость очистки готового кормового продукта от остатков нефти, имеющих канцерогенные свойства.
Другой пригодный вид сырья для производства микробного белка - метанол. На метаноле как на единственном источнике углерода и энергии способны расти около 25 видов дрожжей, в том числе Pichia polymorpha, Pichia anomala, Yarrowia lipolytica. Однако, более выгодным считается выращивание на метаноле метилотрофных бактерий, таких как Methylophilus methylotrophus, так как они используют одноуглеродные соединения более эффективно. Поэтому при росте на метаноле бактерии дают больше биомассы, чем дрожжи. Первая реакция окисления метанола у дрожжей катализируется оксидазой, а у метилотрофных прокариот - дегидрогеназой. Ведутся генноинженерные работы по переносу гена метанолдегидрогеназы из бактерий в дрожжи. Это позволит объединить технологические преимущества дрожжей с эффективностью роста бактерий.( Шлегель Г).
В последнее время интенсивно изучаются дрожжи, обладающие гидролитическими ферментами и способные расти на полисахаридах без их предварительного гидролиза. Использование таких дрожжей позволит избежать дорогостоящую стадию гидролиза полисахаридсодержащих отходов. Известно более 100 видов дрожжей, которые хорошо растут на крахмале как на единственном источнике углерода. Среди них особенно выделяются два вида, которые образуют как глюкоамилазы, так и α-амилазы, растут на крахмале с высоким экономическим коэффициентом и могут не только ассимилировать, но и сбраживать крахмал: Schwanniomyces occidentalis и Saccharomycopsis fibuliger. Оба вида - перспективные продуценты белка и амилолитических ферментов на крахмалсодержащих отходах. Ведутся поиски и таких дрожжей, которые могли бы расщеплять нативную целлюлозу. Целлюлазы обнаружены у нескольких видов, например у Trichosporon pullulans, однако активность этих ферментов низкая и о промышленном использовании таких дрожжей говорить пока не приходится. Дрожжи из рода Kluyveromyces хорошо растут на инулине - основном запасном веществе в клубнях топинамбура - важной кормовой культуры, которая также может быть использована для получения дрожжевого белка.( Роуз Э).
Еще один субстрат, пригодный для получения кормового белка - молочная сыворотка, побочный продукт сыроварения. Молочная сыворотка содержит до 4% лактозы. Способность к ассимиляции лактозы имеется примерно у 20% всех известных видов дрожжей. Гораздо реже встречаются дрожжи, сбраживающие лактозу. Активный катаболизм лактозы особенно характерен для дрожжей из рода Kluyveromyces. Эти дрожжи можно использовать для получения на молочной сыворотке кормового белка, этанола, препаратов β-глюкозидазы.
Этанол широко применяется в химической промышленности как исходное соединение для синтеза многих веществ, как растворитель, экстрагент, антифриз и т.п. Вероятно, у этанола большое будущее и как топлива в двигателях внутреннего сгорания: этанол - гораздо более экологически чистое топливо, чем бензин.
В принципе этанол можно получать из любого источника углеводов, которые сбраживаются дрожжами. Разнообразие потенциальных продуцентов тоже велико: более 200 видов дрожжей способны сбраживать глюкозу.
Крупномасштабное получение этанола в качестве топлива осуществляется в основном в Бразилии и других странах Южной Америки. В качестве источника углеводов используется сахарный тростник и маниока, в качестве продуцента этанола - Saccharomyces cerevisiae.
Перспективным сырьем для получения спирта являются отходы целлюлозно-бумажной и деревообрабатывающей промышленности. Однако, гидролизаты древесины содержат большое количество пентоз. До середины 70-х годов XX в. вообще не были известны дрожжи, активно сбраживающие пентозы. Сейчас такие виды найдены: Pachysolen tannophilus и Pichia stipitis (анаморфа - Candida shehatae). Им прочат большое будущее в производстве спирта из гидролизатов древесных отходов, соломы, торфа и т.п.
В небольших масштабах этанол можно получать и из других субстратов, например из молочной сыворотки, используя сбраживающие лактозу дрожжи из рода Kluyveromyces.
В последние десятилетия разнообразие биотехнологических процессов, в которых используются дрожжи, резко увеличилось. Еще более разнообразны перспективы использования дрожжей: в различных разработках, патентах и т.п. упоминается более 200 видов. Сейчас дрожжи используются для получения различных ферментных препаратов, органических кислот, полисахаридов, многоатомных спиртов, витаминов и витаминных добавок, а также во множестве других мелкомасштабных процессах.
Промышленно важные органические кислоты, продуцируемые микроорганизмами, являются либо конечными продуктами (молочная, масляная, пропионовая кислоты у анаэробных бактерий), либо интермедиатами метаболизма. Последние можно получать с помощью дрожжей. В наибольших масштабах производится лимонная кислота, в основном с помощью Aspergillus niger, с использованием в качестве субстрата мелассы. Однако, ее можно получать и с помощью дрожжей на более дешевых субстратах, таких как парафины нефти или этанол. Сейчас разработаны технологии получения и многих других кислот, например, изолимонной из Candida catenulata, фумаровой из Candida hydrocarbofumarica, яблочной из Pichia membranaefaciens и др. ( Грачёва. И.М.).
Из дрожжевых полисахаридов наиболее известен пуллулан, который получают из дрожжеподобного гриба Aureobasidium pullulans. Он представляет собой β-глюкан, в котором мальтотриозные остатки соединены между собой β (1>6) гликозидными связями. Пуллулан используется в основном в пищевой промышленности в качестве пленочного покрытия. Возможно получение разнообразных по строению и свойствам полисахаридов и из других видов дрожжей. Особенно много внеклеточных полисахаридов образуют дрожжи Cryptococcus, Rhodotorula, Lipomyces.
Многоатомные спирты (глицерин, ксилит, эритрит, арабит) - широко применяются в химической и пищевой промышленности. Перспективным считается способ получения сахароспиртов, таких как глицерин, эритрит и ксилит, с использованием ксеротолерантных дрожжей рода Zygosaccharomyces. Эти дрожжи способны расти в средах с высоким осмотическим давлением, синтезируя при этом большое количество внутриклеточных полиолов, которые служат осмопротекторами. Другой способ касается получения ксилита - важного полиола для пищевой промышленности. Ксилит накапливается как побочный продукт при сбраживании ксилозы дрожжами Pachysolen tannophilus.
Многие дрожжи служат источниками для получения ферментных препаратов, которые используются в современной пищевой и химической промышленности. Из дрожжевого осадка, образующегося как отход пивоварения, получают фермент β-фруктофуранозидазу (инвертазу), расщепляющий сахарозу на глюкозу и фруктозу. Препараты инвертазы широко применяются в кондитерской промышленности для предотвращения кристаллизации сахарозы, для приготовления инвертных сиропов. С помощью культур Kluyveromyces marxianus получают β-галактозидазу, которая применяется в молочной промышленности. Дрожжи Yarrowia lipolytica используются для получения липолитических ферментов, представляющих большой интерес для многих отраслей хозяйства. Липазы используются в сыроварении, в косметической промышленности, при выделке мехов и кож, в моющих средствах. В последние годы разработано множество способов получения самых различных ферментов из дрожжей: пектиназ из Saccharomycopsis fibuliger, амилаз из Schwanniomyces occidentalis, ксиланаз из Cryptococcus laurentii, гидролаз L-α-амино-ε-капролактама из криптококков, алкогольоксидазы из Pichia burtonii, оксидазы D-аминокислот из Trigonopsis variabilis, фенилаланинаммиаклиазы из Rhodotorula glutinis. Это лишь немногие примеры получения дрожжевых ферментных, спектр которых в последние годы постоянно расширяется.
Применение дрожжей как источников витаминов началось в 1930-е годы. Одним из первых промышленных процессов получения витаминов было выделение эргостерина из Saccharomyces cerevisiae с последующим облучением ультрафиолетом для перевода в витамин D. Затем у дрожжей была открыта способность к сверхсинтезу некоторых витаминов группы В, в частности рибофлавина. Некоторые красные дрожжи используются для получения каротиноидов, в частности β-каротина, служащего предшественником витамина A, астаксантина, используемого в качестве кормовой добавки в рыбоводстве. Кроме производства индивидуальных витаминов уже много лет в мире практикуется получение автолизатов и гидролизатов дрожжей, питьевых дрожжей, которые используются как источник витаминов и как вкусовые добавки ( И.М. Грачёва, Л.А. Иванова. В.М. Кантере).
1.4 Систематика дрожжей
Одноклеточная организация дрожжей накладывает столь существенный отпечаток на их внешний облик и на методы работы с ними, что систематика дрожжей долгое время развивалась вполне независимо от систематики мицелиальных грибов. Одно из важных отличий - широкое использование для классификации и идентификации дрожжей физиологических и биохимических признаков. До середины XX в. все одноклеточные грибы рассматривались в качестве достаточно обособленной таксономической группы аскомицетов. Последней точки зрения придерживался, например, В.И.Кудрявцев, автор отечественного определителя дрожжей, который предлагал объединять все дрожжи в самостоятельный порядок Unicellomycetales. В середине XX в. произошло принципиальное событие в систематике дрожжей, когда японскому микологу Исао Банно удалось индуцировать половой цикл размножения у гетероталличных красных дрожжей Rhodotorula glutinis. Полученные им характеристики жизненного цикла однозначно свидетельствовали о принадлежности этих дрожжей к базидиомицетам. Стало очевидным, что среди дрожжей имеются представители совершенно различных таксономических групп грибов, как аскомицетовых, так и базидиомицетовых. После этого большое внимание в систематике дрожжей стало уделяться поиску признаков, позволяющих разделить аскомицетовые и базидиомицетовые виды, даже без наблюдения полного жизненного цикла (так называемых признаков аффинитета). В систематике дрожжей стали активно использоваться биохимические и цитологические признаки.( Хиггинс И., Бест Д., Джонс Д.М.).
Современный период изучения биологического разнообразия характеризуется интенсивным развитием филогенетической систематики, которая направлена на реконструкцию конкретных путей исторического развития организмов. В микробиологии филогенетическая систематика получила мощный импульс развития лишь в самом конце XX в. в связи со сравнительным изучением консервативных нуклеотидных последовательностей в рРНК. К настоящему времени расшифрованы и помещены в компьютерные банки данных, доступные по сети Интернет, нуклеотидные последовательности рРНК у представителей всех известных видов дрожжей. Это позволяет строить филогенетические деревья, отражающие эволюцию их рибосомальных генов.
Оказалось, что группирование дрожжей на основе сходства нуклеотидных последовательностей рРНК во многих случаях не совпадает с группированием по фенотипическим признакам. Многие традиционные признаки, используемые в классификации дрожжей, такие как характеристики вегетативного размножения, форма аскоспор, способность к сбраживанию и ассимиляции сахаров, стали считаться ненадежными, не пригодными для определения филогенетического родства. Секвенирование рРНК (рДНК) сейчас считается необходимым при описании новых видов дрожжей.( Главачек Ф.).
Один из главных вопросов, который активно дискутировался до последнего времени, положение дрожжей в общей системе грибов. Являются ли они предковыми примитивными формами аско- и базидиомицетов, давшими начало более продвинутым и сложно организованным мицелиальным грибам, или вторично упростившимися, возникшими независимо в разных филогенетических линиях грибов в результате конвергенции? Окончательный ответ на этот вопрос был получен лишь недавно в результате развития молекулярно-филогенетической систематики. Сейчас считается окончательно доказанным полифилетическое происхождение дрожжей, их независимое возникновение среди аскомицетовых и базидиомицетовых грибов. После обнаружения базидиомицетовых дрожжей в зимологии возникло представление о дрожжах, как о чисто морфологической, или экоморфологической группе грибов (жизненной форме), лишенной таксономического содержания. В то же время, дрожжи встречаются лишь в некоторых филогенетических линиях грибов, в которых имеются также близкородственные виды, существующие в основном в мицелиальной форме. Примерами могут служить аскомицеты Endomyces, Blastobotrys, базидиомицеты Tilletiopsis, Trichosporonoides, не образующие почкующихся одиночных клеток. Несмотря на отсутствие одноклеточных ассимилятивных стадий такие виды также включают в определители дрожжей, так как филогенетически они очень близки к «настоящим» одноклеточным дрожжам. Поэтому с точки зрения филогенетической систематики, целиком сводить понятие «дрожжи» только к одноклеточной жизненной форме грибов не представляется целесообразным.
Систематика дрожжей, поиск об их места в общей системе грибов продолжают активно развиваться, и в этой области еще не выработано устоявшихся, стабильных представлений. Тем не менее, со времени первых описаний сахаромицетов зимологами пройден очень большой путь в исследовании разнообразия дрожжевых грибов. Основные этапы этого пути отражены в серии определителей голландской зимологической школы, которые выходили с интервалом в 10-20 лет.( Коновалов С.А.).
Понятие вида - одно из сложнейших в биологии. Разработка концепции вида - особенно трудная задача в применении к микроорганизмам, в частности к грибам, по причине их плеоморфизма, сложности жизненных огрпмпциклов, наличия стабильных несовершенных форм, неопределенности границ индивидуума и популяции.
В биологии термин «вид» используется в разных значениях. С одной стороны, о виде говорят как о наименьшей единице классификации, минимальном элементе разнообразия, который мы в состоянии распознать с помощью определенного набора таксономических признаков. Стандартный набор таких признаков, используемых в таксономии дрожжей, постоянно увеличивается, что позволяет выделять все более «мелкие» виды. В результате число известных видов дрожжей за последние десятилетия существенно возросло не только за счет обнаружения новых форм в природе, но и дробления уже известных «крупных», «гетерогенных» видов, характеризующихся значительной изменчивостью. Границы между видами при этом проводятся либо исходя из опыта и интуиции систематика (типологическая концепция вида), либо на основании явного соглашения между систематиками об уровне отличий, достаточном для выделения самостоятельного вида (номиналистическая концепция). В последнем случае вид - это не более чем абстракция, и границы вида устанавливаются исходя из чисто утилитарных представлений об определенном уровне общего сходства между штаммами дрожжей.( Коновалов С.А.).
Наряду с этим в биологии существует и принципиально иное представление о виде, как о целостной, устойчивой и достаточно гетерогенной системе. При этом основное внимание уделяется не столько уровню различий между особями, сколько степени дискретности, отсутствию переходных форм между видами. Такая дискретность наиболее выражена у животных и растений, то есть организмов, размножающихся преимущественно половым путем. Обмен генами при половом размножении как раз и представляет собой механизм, поддерживающий целостность вида, а прекращение такого обмена приводит к возникновению дискретности разнообразия. Поэтому для животных и растений применима биологическая концепция вида: вид - это система популяций, генетически изолированных от популяций других видов и характеризующихся интерфертильностью, то есть способностью особей скрещиваться с образованием плодовитого потомства.
Организмы разных видов не могут скрещиваться, или скрещиваются, но не дают плодовитого потомства. Такая концепция вида применима и ко многим грибам, у которых имеется половой процесс. Изучение интерфертильности играет существенную роль в определении границ видов и у совершенных дрожжей с хорошо выраженной половой стадией в жизненном цикле.
Интерфертильность легко проверяется, если имеются штаммы, представляющие различные типы спаривания гетероталличных дрожжей. Однако гомоталлизм, вегетативное размножение в диплоидной стадии, конъюгация аскоспор в аске - затрудняют применение интерфертильности для разграничения видов дрожжей.( Аркадьева З.А., Безбородов А.М., Блохина И.Н.).
Применение биологической концепции вида к дрожжевым грибам осложняется и тем, что половое размножение у них не является обязательным и не играет такой же существенной роли в формировании разнообразия, как у высших животных и растений. Очевидно, биологическая концепция неприменима к несовершенным дрожжам, размножающимся только бесполым путем, и, возможно, полностью утерявшим половую стадию в ходе эволюции. У таких дрожжей выделение видов неизбежно носит номиналистический характер.
В связи с развитием молекулярно-филогенетической систематики в последнее время изменилось и представление о природе вида у дрожжей. Бурное развитие геносистематики привело к созданию и широкому внедрению новых методов, включая расшифровку и сравнение нуклеотидных последовательностей рДНК, ПЦР-анализ амплифицированной ДНК и др. Это породило надежды на создание абсолютно объективных технологий видовой идентификации. На первый план вышла концепция «элементарных» монофилетических видов, то есть таких групп штаммов, внутри которых полностью отсутствует филогенетическая структура, выявляемая на основании анализа нуклеотидных последовательностей в наиболее консервативных генах. Самостоятельность многих видов дрожжей стала активно пересматриваться с молекулярно-генетических позиций. Это вызвало определенное «высокомерие» по отношению к классическим представлениям о смысле выделения видов и видовой формы организации вообще. В связи со сложностью и дороговизной молекулярно-генетических методов возникла проблема практической недостижимости «правильной» видовой идентификации при проведении исследований, требующих массового определения большого числа штаммов, например, экологических, инвентаризационных, биоресурсных. Вместе с тем, на фоне сохраняющегося пиетета перед молекулярно-генетическими методами в последнее время появляется все больше свидетельств их недостатков, спорности некоторых положений, противоречий с эволюционно-филогенетическими концепциями. Иными словами, возникла проблема соотношения новейших молекулярных подходов к выделению видов с традиционными, основанными на морфологических и физиологических признаках. Решение этой проблемы должно определить развитие систематики дрожжей в ближайшем будущем.( Коновалов С.А.).
Набор признаков, на основании которых выделяются виды у дрожжей, постоянно меняется в связи с принятием той или иной концепции вида, в результате пересмотра таксономической значимости признаков, с появлением новых методов и технологий. Систематика грибов до последнего времени основывалась главным образом на морфологических признаках, таких как пигментация, строение конидиеносцев, форма спор и т.п. Одноклеточные грибы не обладают такой сложной разнообразной морфологией, как мицелиальные. Поэтому уже с первых работ Э.Хансена и А. Клюйвера в 20-х гг. XX в. разделение видов дрожжей основывалось не только на морфологических, но и на физиологических признаках, таких как способность к сбраживанию и аэробной ассимиляции различных углеводов. Количество используемых для описания вида источников углерода и азота было значительно расширено в 50-е гг. Викерхэмом, который также разработал стандартные среды для постановки физиологических тестов. Эти критерии прочно вошли в практику классификации и идентификации дрожжей и используются до настоящего времени.
По своей природе признаки, используемые в систематике дрожжей, можно разбить на следующие группы.
Макроморфологические (культуральные) признаки, которые характеризуют рост штамма на различных средах. К ним относятся особенности роста в жидких средах (образование пленки, мути, осадка), формирование гигантской колонии и ее характеристики, образование плодовых тел.( Работнова И. Л).
Микроморфологические признаки - особенности клеточной морфологии: размеры и форма клетки, тип вегетативного размножения, строение мицелия и псевдомицелия, формирование бесполых спор (баллистоспор, хламидоспор), характеристики полового размножения (гологамия или педогамия, форма аскоспор и др.
Цитологические признаки - особенности строения клеток и клеточных структур, например, строение клеточной стенки, структура септ мицелия.
Физиологические признаки, определяющие тип питания и способность к росту в различных условиях. К ним относится определение способности к анаэробному сбраживанию или аэробной ассимиляции различных источников углерода, способность к росту при различных значениях pH, осмотического давления среды, устойчивость к различным ингибиторам роста.( Шлегель Г).
Биохимические признаки, характеризующие химический состав клетки и отдельных ее компонентов: образование ферментов, специфических метаболитов, внеклеточных продуктов, например, моносахаридный состав внеклеточных полисахаридов.
Генетические признаки, включающие характеристики генома.
Арсенал генетических признаков и методов их определения особенно расширился в последнее время в связи с интенсивным развитием молекулярной биологии и стал играть ключевую роль в систематике дрожжей. К ним относятся нуклеотидный состав ДНК, степень гомологии ДНК у разных видов, наличие уникальных олигонуклеотидных последовательностей в геноме, последовательность нуклеотидов в определенных генах.
Экологические признаки, определяющие характер распространения вида в природных местообитаниях, а также чувствительность или резистентность к различным экологическим факторам, патогенные свойства.
Для выявления всех этих признаков разработаны стандартные методы, описываемые в определителях или специальных руководствах.
Морфологические характеристики, имеющие наибольшее значение для дифференциации родов дрожжей, были подробно рассмотрены выше. Для разделения видов у дрожжей традиционно использовались в основном физиологические характеристики - способность к росту на различных источниках углерода и азота.
Некоторые цитологические и биохимические критерии, разработанные в последние десятилетия, сыграли особенно большую роль в классификации дрожжей на родовом и надродовом уровне, значительно изменив представления об их группировании и филогении. Эти признаки имеет смысл рассмотреть более подробно.
Изучение полисахаридов, которые составляют клеточную стенку и капсулу, оказало существенное воздействие на систематику и преставления о филогении дрожжей. Характеристика моносахаридного состава полисахаридов клеточных стенок используется главным образом для дифференциации дрожжей на родовом и надродовом уровне. В то же время, детальные исследования химического состава клеточной стенки были проведены лишь у небольшого числа видов дрожжей. Наиболее подробно исследовано строение клеточной стенки Saccharomyces cerevisiae и нескольких близких аскомицетовых видов.( Гриневич. А.Г., Босенко. А.М).
Как уже отмечалось, аскомицетовые почкующиеся дрожжи содержат в качестве главного структурного компонента клеточной стенки β (1>3)-глюкан. Другой существенный компонент - комплекс белка и глюкоманнана. Оказалось, что боковые цепи этих полисахаридов, особенно маннана, существенно варьируют по моносахаридному составу у разных видов дрожжей. Моно- и олигосахариды, образовавшиеся при кислотном гидролизе углеводов клеточной стенки, можно разделить с помощью гельфильтрации.
Другой способ, применявшийся для характеристики полисахаридов - сравнение спектров протонного магнитного резонанса, который позволяет определять пропорции и размер боковых цепей в различных маннанах. Считается, что сходные спектры протонного магнитного резонанса клеточных маннанов указывают на близкое родство видов. Эти характеристики оказались очень полезными для классификации дрожжей, например, для группирования родственных видов в многовидовых сборных анаморфных родах типа Candida.
Наряду с глюканом и маннаном почкующиеся аскомицетовые дрожжи содержат около 1-2 % хитина, который почти полностью локализован в областях шрамов почкования. Однако небольшое количество хитина (около 0.1 %) рассеяно по всей клеточной стенке.( Грачёва. И.М.).
Напротив, дрожжи базидиомицетового аффинитета характеризуются намного более высоким содержанием хитина (до 10 %). Таким образом, это различие можно использовать в качестве таксономического признака для разделения аскомицетовых и базидиомицетовых анаморф. Кроме того, оказалось, что содержание хитина в стенках некоторых мицелиальных аскомицетовых дрожжей, например, у видов Saccharomycopsis, значительно выше, чем у истинных одноклеточных дрожжей, таких как Saccharomyces cerevisiae.( http://soil.msu.ru/soilyeasts/pics/AscosporeForms.htm).
Наиболее отличным по моносахаридному составу оказался состав клеточной стенки делящихся дрожжей Schizosaccharomyces. Виды этого рода содержат в дополнение к β-глюканам другой главный структурный полисахарид, а именно α(1>3)-глюкан. Маннан Schizosaccharomyces также отличается по строению от маннана почкующихся дрожжей, главным образом присутствием галактозных остатков. Это позволило предположить, что делящиеся дрожжи имеют уникальный состав клеточной стенки и не родственны другим группам аскомицетовых дрожжей. Позднее это предположение было подтверждено данными по сравнению нуклеотидных последовательностей рРНК.
Еще большее значение играют характеристики моносахаридного состава клеточных стенок в систематике базидиомицетовых дрожжей. Особенно ценным считается такой признак, как присутствие или отсутствие D-ксилозы в клеточной стенке или в экстрактах целых клеток. По этому признаку все гетеробазидиомицетовые дрожжи были разбиты на две группы: спороболомицетовые (отсутствует ксилоза и часто содержится фукоза), которые включают виды родов Rhodotorula, Rhodosporidium, Sporobolomyces, и филобазидиевые (содержат ксилозу и обычно глюкуроновую кислоту), включающие роды Bullera, Cryptococcus, Filobasidium, Phaffia и некоторые виды Trichosporon. Такое разделение также подтверждается другими молекулярно-биологическими критериями.
Несмотря на несомненную важность такого признака, как состав углеводов клеточной стенки, следует подчеркнуть, что он не является решающим критерием в систематике дрожжей, а ценен только в комбинации с другими хемотаксономическими и молекулярными признаками, включая анализ последовательности рРНК. Такой полифазный подход для создания надежной таксономической системы поддерживается большинством систематиков.( Бабицкая В.Г., Стахеев И.В.).
Дрожжи и дрожжеподобные грибы содержат в качестве одного из компонентов цепи переноса электронов кофермент Q, или убихинон.
Убихиноны - группа соединений, в которых к 2,3-диметоксил-5-метилбензоксихинону присоединена в 6 положении боковая цепь из нескольких изопреноидных остатков. У известных гомологов кофермента Q количество изопреноидных остатков варьирует от 5 до 10. По количеству изопреноидных остатков различают до шести типов кофермента Q от Q-5 до Q-10. У базидиомицетовых дрожжей обнаружен также дигидрогенированный гомолог кофермента Q с насыщенной двойной связью в изопреноидных остатках, обозначаемый как Q-10 (H3). Кофермент Q выделяют с помощью тонкослойной хроматографии из гексанового эктракта гидролизованных клеток дрожжей. Для определения типа кофермента Q используют различные хроматографические методы, включая жидкостную, тонкослойную и бумажную хроматографию, а также масспектрометрию.
Тип кофермента Q оказался очень полезным признаком для классификации дрожжей и дрожжеподобных грибов. Прежде всего, он различен у аскомицетовых и базидиомицетовых дрожжей. У первых преобладают убихиноны с 5-7 изопреноидными остатками (Q-5 - Q-7), у вторых - с 8-10 (Q-8 - Q-10). Однако, имеются и исключения, например, убихинон Q-10 обнаружен у представителей родов Lipomyces и Schizosaccharomyces. Особенно важную роль сыграл тип кофермента Q в классификации анаморфных дрожжей на родовом уровне. Считается, что этот признак не должен существенно варьировать внутри рода, и отличия по типу кофермента Q достаточно для отнесения видов к разным родам в том случае, когда это сопровождается и другими существенными различиями, например, по морфологическим признакам.
Определение типа кофермента Q, вместе с изучением моносахаридного состава клеточных стенок сыграло решающую роль в переклассификации родов анаморфных баллистоспоровых дрожжей (Bensingtonia, Bullera, Sporobolomyces, Udeniomyces), дрожжей, характеризующихся образованием почек на стеригмах (Sterigmatomyces, Fellomyces, Kurtzmanomyces). Все эти роды характеризуются одним типом кофермента Q. В то же время, в таких родах, как Cryptococcus, Candida, тип кофермента Q варьирует по видам, что подтверждает их условность и филогенетическую гетерогенность.
Развитие методов электронной микроскопии позволило использовать для классификации дрожжей ряд цитологических признаков. Выше уже были рассмотрены такие характеристики, как ультраструктура клеточной стенки, цитологические особенности образования почки (голобластическое и энтеробластическое почкование), которые оказались различными у аскомицетовых и базидиомицетовых дрожжей. Еще одним важным цитологическим признаком является ультраструктура септ мицелия у диморфных дрожжеподобных грибов. Деление клеток мицелия начинается с образования тонкого кольца на клеточной мембране. Кольцо начинает центростремительно расти и разделяет клетку. Затем на внешней поверхности мембраны откладывается вновь синтезируемый материал клеточной стенки, формируя септу.
Детальные исследования, проведенные с помощью электронной микроскопии, показали, что ультраструктура этих септ существенно различается у разных групп грибов и может служить хорошим критерием для их филогенетической классификации.
В гифах аскомицетовых дрожжеподобных грибов септы в основном гомогенные и электроннопрозрачные. В септах имеются поры, которые достаточно велики для прохода ядер. С обеих сторон поры часто располагаются мелкие мембранные пузырьки, так называемые тельца Воронина. Гифы дрожжеподобных грибов рода Ambrosiozyma имеют септы с сильно утолщенным центральным участком. У некоторых дрожжеподобных грибов в центре сформированной септы имеется лишь очень узкий мембранный канал, так называемая микропора. У других видов в септе могут формироваться множественные каналы - плазмодесмы. Наличие таких плазмодесм явилось важным свидетельством о наличии филогенетической связи анаморфного рода Zygozyma с семействами Lipomycetaceae и Dipodascaceae.( Гречушкина Н.).
У большинства базидиомицетовых дрожжей в центре септы формируется пора, имеющая сложное строение: края септы раздуты в виде тора, а с двух сторон поры имеются характерные мембранные образования - парентосомы. В некоторых исследованиях было показано, что тороидально раздувшиеся септы (долипоры) на самом деле представляют собой артефакт химической фиксации, используемой при подготовке образцов к электронной микроскопии. Такие бочкообразные вздутия отсутствовали в образцах, подготовленных с помощью быстрого замораживания. Тем не менее, эти артефакты четко воспроизводятся у одних и тех же видов, коррелируют с другими таксономическими признаками и поэтому могут использоваться в систематике. Тонкое строение комплекса долипор и парентосом служит важным диагностическим признаком для классификации базидиомицетовых дрожжеподобных грибов.
Аскомицетовые и базидиомицетовые грибы легко отличить по характеру полового размножения: формированию эндогенных спор в асках у аскомицетов и экзогенных спор на базидиях у базидиомицетов. Аналогичные структуры формируют при половом размножении и дрожжевые грибы. Поэтому особую сложность для классификации представляют анаморфные дрожжи, у которых отсутствует половая стадия в жизненном цикле. Формально такие грибы относят к особому классу Deuteromycetes, однако по сути они представляют собой лишь стадии в полном жизненном цикле аскомицетов или базидиомицетов. Половое размножение у таких дрожжей может отсутствовать по разным причинам. Во-первых, многие дрожжи гетероталличны, и для осуществления полового процесса необходимы штаммы разных типов спаривания. В чистой культуре таких дрожжей, представленной только одним типом спаривания, половое размножение невозможно. Во-вторых, половой процесс может запускаться лишь в определенных условиях, например, при наличии определенных химических факторов, которые могут отсутствовать в лабораторной среде. Наконец, у многих видов способность к половому размножению, по-видимому, вообще утеряна в ходе эволюции.( Грачёва. И.М.).
По совокупности морфологических и физиологических признаков, которые использовались на первых этапах развития систематики дрожжей, отличить аскомицетовые и базидиомицетовые дрожжи в анаморфном состоянии было практически невозможно. Это привело к тому, что некоторые крупные роды несовершенных дрожжей включали анаморфы как аскомицетов, так и базидиомицетов. В первую очередь это относится к роду Candida, описанному в 1923 г. Диагноз рода был очень расплывчатым: «Немногочисленные гифы, стелющиеся, распадающиеся на короткие и длинные фрагменты. Конидии, возникающие путем почкования из гиф или на вершине одна другой, мелкие и бесцветные». Под такое описание подходили самые различные дрожжеподобные грибы, и поэтому в дальнейшем оказалось возможным включение в этот род многих видов, явно неродственных друг другу. К 1970 г., в котором был выпущен полный определитель дрожжей дельфтской школы, количество видов, включенных в род Candida, возросло до 81, и он стал самым многовидовым родом среди дрожжей.( Азов а Л. Г.).
Второй по числу видов дрожжевой род Torulopsis существовал с 1895 г. и объединял аспорогенные дрожжи, не соответствующие описанию рода Candida только по одному признаку - отсутствию способности к образованию субстратного септированного или псевдомицелия. При росте на плотных средах мицелиальность настолько меняет облик колонии дрожжеподобных грибов, что на начальном этапе систематики дрожжей, когда основной упор делался именно на морфологические характеристики, этому признаку безусловно был придан статус родового. Однако с увеличением разнообразия описанных видов стало ясно, что способность к образованию псевдомицелия крайне ненадежный, сильно варьирующий в зависимости от штамма и от условий культивирования признак, имеющий низкую таксономическую ценность. В связи с этим в 1978 г. было предложено объединить роды Candida и Torulopsis в один род. Это было осуществлено в следующем издании определителя дрожжей, где был представлен единый род Candida, включающий 196 видов и заведомо полифилетический. Наиболее вескими аргументами полифилетичности рода были обнаружения совершенных стадий для некоторых видов Candida, которые, как оказалось, соответствовали различным родам известных аскоспоровых дрожжей. Такие пары анаморфа - телеоморфа включали, например Candida famata - Debaryomyces hansenii, Candida pulcherrima - Metschnikowia pulcherrima, Candida robusta - Saccharomyces cerevisiae и др. В 1966 г. новозеландская исследовательница Ди Менна описала три новых вида Candida gelida, Candida nivalis, Candida frigida, выделенные ею из антарктических почв. Всего несколько лет спустя у этих дрожжей также были обнаружены совершенные стадии, которые свидетельствовали об их принадлежности к базидиальным грибам. Таким образом, род Candida оказался группой несовершенных дрожжей, объединяющей анаморфы как аскомицетов, так и базидиомицетов.( И.М. Грачёва, Л.А. Иванова. В.М. Кантере.).
После доказательства полифилетической природы таких крупных дрожжевых родов, как Candida, в зимологии начался активный поиск признаков, которые могли бы дифференцировать анаморфы аско- и базидиомицетов. К настоящему времени в систематике дрожжей используется целый набор таких признаков аффинитета, благодаря которым все дрожжи удается четко разбить на две группы - аскомицетовые и базидиомицетовые, независимо от телеоморфного или анаморфного состояния культуры.
Развитие методов секвенирования рРНК окончательно решило проблему определения аффинитета несовершенных дрожжей. Одно из главных преимуществ систематики, основанной на сравнении нуклеотидных последовательностей консервативных генов - возможность классификации на одной и той же основе как совершенных видов дрожжей, обладающих полным жизненным циклом, так и их анаморф.( Розманова Н.В., Бочарова Н.Н.).
Вновь описываемые виды должны типифицироваться штаммами, которые помещают в крупные коллекции, где они поддерживаются в живом состоянии. Это делает их доступными для научной общественности. Кроме хранилищ таких штаммов коллекции выполняют различные функции: научные, учебные, производственные. Они проводят патентование практически ценных штаммов, осуществляют обмен и выдачу культур для разных целей, проводят таксономические исследования, составляют периодически публикуемые каталоги. Коллекции дрожжей различаются как по своему объему, так и по направленности. Есть очень крупные, хорошо известные в научном мире коллекции, где проводятся широкие исследования по систематике дрожжей, разрабатываются способы наилучшего хранения штаммов. Есть и небольшие, но очень ценные коллекции, где собраны штаммы с конкретной целью, служащие для выполнения специальных исследований.( Жвирблянская А.Ю., Исаева В.С.).
Крупнейшая коллекция дрожжей - CBS (Centraalbureau voor Schimmelcultures). Эта коллекция была создана в 1904 г. по решению 11-го международного Ботанического Конгресса в Вене. Она поддерживается Королевской Нидерландской Академией Искусств и Наук и до 2000 г. располагалась на родине Левенгука в г. Дельфте. В настоящее время коллекция CBS находится в г.Утрехте и является мировым центром по изучению систематики дрожжей. Главным образом на базе этой коллекции была создана серия определителей дрожжей, содержащих описания всех известных видов и диагностические ключи для их идентификации.( Бабьева И.П., Голубев В. И.).
Среди других крупных коллекций дрожжей ВКМ (Всероссийская коллекция микроорганизмов) и ВКПМ (Всероссийская коллекция промышленных микроорганизмов) в России, ATCC (American Type Culture Collection) в США, IFO (Institute of Fermentation in Osaka) в Японии, CCY (Culture Collection of Yeasts) в Словакии, NCYC (National Collection of Yeast Cultures of the United Kingdom) в Англии. Существует также ряд крупных специализированных коллекций дрожжей, например, генетически модифицированных штаммов Saccharomyces cerevisiae, штаммов, используемых в виноделии и других биотехнологических процессах.
Основная проблема, с которой сталкиваются работники микробиологических коллекций - необходимость длительного поддержания чистых культур в жизнеспособном состоянии. Для хранения дрожжевых культур используются разные методы, каждый из которых имеет свои преимущества и недостатки.( Бабицкая В.Г., Стахеев И.В.).
Наиболее доступный и широко применяемый метод хранения - поддержание культур путем их периодических пересевов, обычно в пробирках со скошенным агаром. Сроки пересевов определяются скоростью высыхания среды и зависят от температуры и влажности помещения. Промежутки между пересевами можно увеличить за счет более плотного закупоривания пробирок и снижения температуры хранения. Хранение в холодильной камере при температуре около 5°C дает возможность увеличить сроки пересевов до 2-3 лет. Для предотвращения высыхания культур используют заливку культур минеральным маслом. Этот способ позволяет сохранять культуры большинства видов дрожжей без пересевов в течение 10 и более лет.( Аркадьева З.А.).
Другой способ, используемый для длительного хранения дрожжевых культур - лиофилизация, то есть высушивание под вакуумом из замороженного состояния. Лиофилизированные культуры хранят в запаянных стеклянных ампулах при комнатной температуре или в холодильнике. Такие культуры могут сохраняться в жизнеспособном состоянии в течение нескольких десятилетий.
Недостатком этого способа является невозможность визуального контроля за жизнеспособностью культуры. Кроме того, не все виды дрожжей выдерживают процесс лиофилизации, а при длительном хранении лиофилизированных культур могут происходит существенные изменения в их метаболизме.( Хиггинс И., Бест Д., Джонс Д.М).
В последнее время все шире применяется еще один способ длительного хранения культур микроорганизмов - замораживание в жидком азоте. Замороженные в ампулах культуры хранят в специальных контейнерах-рефрижераторах с жидким азотом при температуре -196°C. Такой способ позволяет сохранять жизнеспособные культуры дрожжей в течение практически неограниченного времени.( Безбородов А.М.).
Определение видовой принадлежности дрожжей - сложная процедура, требующая не только большого опыта, но и, как правило, достаточно длительных лабораторных исследований, связанных с постановкой серии тестов для определения рассмотренных выше морфологических, физиологических и биохимических признаков. Лишь после составления достаточно полного описания штамма возможна его надежная видовая идентификация. В последнее время для идентификации дрожжей по таким описаниям, наряду с традиционными дихотомическими ключами, широко используются компьютерные технологии нумерической идентификации. Такая идентификация может осуществляться на основе любой СУБД (средство управления базами данных), в которую внесены стандартизованные признаки всех видов дрожжей. В процессе идентификации программа поочередно сравнивает описание идентифицируемого штамма с описанием каждого вида и высчитывает уровень сходства (долю совпавших признаков от общего количества использованных признаков). Результирующая информация представляет собой список видов, ранжированный по уровню сходства с идентифицируемым штаммом. Существуют специализированные программы для идентификации дрожжей. (Розманова Н.В., Бочарова Н.Н.).
Некоторые коллекции дрожжей предоставляют возможность поиска наиболее сходных штаммов с использованием Интернета. В последние годы бурно развивается система генобанков, доступных также через Интернет, позволяющих искать наиболее сходные нуклеотидные последовательности. Однако следует помнить, что при идентификации с использованием таких формальных процедур возможны серьезные ошибки, поэтому для надежного определения вида дрожжей необходима консультация со специалистом-систематиком, имеющим большой опыт изучения разнообразия этих организмов. В первую очередь это относится к идентификации штаммов, выделенных из природных местообитаний.
2 Общая характеристика хмеля
Humulus lupulus L
Название рода humulus – средневековое латинизированное славянское или голландское наименование хмеля, латинское “lupulus” – от итальянского “luppolo” – хмель.
Двудомное многолетнее травянистое вьющееся растение (лиана). Стебель длиной до 3 – 6 м, гранистый, цепкошероховатый от загнутых шипиков. Корневище мясистое, ползучее.
Листья супротивные, на верхушечных ветках иногда очередные, черешковые, округлые или овальные, трех-, пятипальчатолопастные, по краю крупнопильчатые с остроконечными зубцами, сверху темно-зеленые, острошероховатые, снизу более бледные, железистые, по жилкам с редкими острыми цепкими шипиками. Черешки длинные, шероховатые. (Н.И. Ляшенко, 1976).
Цветки мелкие, однополые; растение двудомное – пестичные и тычиночные цветки развиваются на разных экземплярах. Тычиночные (мужские) цветки на тонких цветоножках, поникшие, с пятичленным, желтовато-зеленым околоцветником, расположены пазушными верхушечными висячими метелками. Пестичные цветки (женские) на очень коротких цветоножках находятся в коротких пазушных колосках, длиной 2 – 3 см. Околоцветник малозаметный, чашевидный, плотно охватывает нижнюю половину завязи. Прицветники после цветения разрастаются, образуя “шишки”. Плод – килеватый сплющенный орешек. “Шишки” несут желтые железки. Цветет в июле – августе. (В.М. Шуляр, И.Г. Рейтман, С.А. Зинчинко, 1980).
Растет по берегам рек в зарослях кустарников и по опушкам пойменных лесов. Распространен почти по всей европейской части России, на Кавказе, в Сибири, Средней Азии. Широко возделывается на Украине, в Беларуси, Поволжье, Восточной и Западной Сибири, в центрально-черноземных областях, на Алтае и Кавказе. (А.Н. Александров, 1975)
Заготовляют шишки в начале созревания (август, начало сентября), срывая руками, когда они еще зеленовато-желтого цвета. Сушат быстро под открытым небом, в тени, на чердаках или под навесом с хорошей вентиляцией, расстилая их тонким слоем на мешковине или бумаге. Лучшее сырье получается при сушке в сушилках. Не следует забывать, что хмель ядовит.
Железки, находящиеся на составных частях соплодий (“шишках”), во время созревания легко отделяются. Путем отряхивания “шишек” и просеивания получают зеленовато-желтый порошок из железок, называемый лупулином. Железки, иногда называемые липучки, составляют 7—16% массы сухих “шишек”.(В.Н. Виноградов, Л.Сергеев, 1977)
Корневая система вегетативно размножаемых растений хмеля состоит из 10-12 и более сильно разветвленных толстых скелетных корней, покрытых корообразным слоем. Корни отрастают из главного корневища – подземного видоизмененного побега. Скелетные корни многократно ветвятся на более тонкие корни с густой сетью мелких корешков и образуют мощную корневую систему, проникающую в глубину до 4 метров и в ширину до 3 метров.
Конечные разветвления корешков имеют корневой кончик, который постоянно нарастает. За корневым кончиком расположена небольшая всасывающая зона корешков, покрытая корневыми волосками, которые представляют собой отростки клеток эпидермиса с очень тонкой оболочкой.
Корневые волоски, поглощающие воду и питательные вещества из почвы, перемещаются за растущим кончиком корня.
По данным Крыловой М.И.(С.А. Коновалов, 1962) и других исследователей после отмирания корневых волосков на поверхности корешка остается только первичная корка, клетки которой имеют корообразные стенки и защищают внутреннюю ткань корня от повреждений и высыхания.
Кроме того, на подземной части стеблей, главном и боковых корневищах образуются мелкие мочковатые корешки, произрастающие главным образом в пахотном горизонте. Они покрыты тонким корообразным слоем, имеют более светлую окраску, чем скелетные корни. Многолетние корни хмеля являются резервными органами. В толстых корнях и в особых корневых утолщениях накапливаются запасные питательнее вещества. Эти корневые утолщения образуются на корнях примерно, на расстоянии 40 см от главного корневища и имеют продолговатую форму.
В течение вегетационного периода по данным И.Г. Рейтмана, Н.И. Ляшенко, М.А. Кулинич (1983), у хмеля наблюдается два периода роста корней - весеннее – летний и осенний. Первый период предшествует активному росту надземной массы и сопровождается усиленным приростом корней в длину. Вторая волна роста корней - осенняя, в период затухания роста стеблей. В этот период особенно усиленно идет процесс накопления общей массы корней и отложения в ней запасных питательных веществ.
Виноградов В.Н. (1977) утверждает, что главное корневище хмеля представляет собой многолетний подземный орган побегового происхождения (ботаническое название каудекс) с расположенными на нем почками. У плодоносящего растения его диаметр достигает 15 см. С возрастом главное корневище разрастается и сильно деревенеет, причем в год посадки разрастание главного корневища вначале происходит медленно, а после образования мощной надземной части растения- более интенсивно. Самым большим прирост главного корневища хмеля бывает в первые 3-4 года после посадки растения. Именно в этот период на нем образуется наибольшее количество почек.
По некоторым данным на главном корневище хмеля ежегодно образуются боковые корневища – видоизмененные, развивающиеся в горизонтальном направлении подземные побеги с почками. Боковые корневища имеют относительно короткие междоузлия, они развиваются за счет резервных веществ подземной части растения.
Стебли у хмеля тонкие, длинные вьющиеся лианы. При толщине не более 13 мм, они достигают в длину 10-12 метров, а потому не могут самостоятельно держаться вертикально и пользуются для этого соседними растениями или другими опорами.
Характерной особенностью строения стебля хмеля как лианы является отсутствие прочного скелета, наличие крупных длинных проводящих сосудов и облегченная масса растения за счет небольшого запаса питательных веществ в самих стеблях и полного их строения. Прочность и гибкость стебля хмеля по данным (Либацкого Е.П. А.Б. Остроменьский 1979) обеспечивается особенностью его строения: наличием лубяных волокон в стенках стебля и диафрагм в его узлах.
Побег хмеля представляет собой стебель с листьями и другими расположенными на нем органами, имеет свои особенности.
Листья у хмеля простые черешковые с небольшими прилистниками у основания. Черешки листьев имеют ту же окраску, что и стебли. Поверхность листовой пластинки пальчатораздельная, у основания сердцевидной формы (А.Б Остроменьский, 1979).
Соплодия (“шишки”) хмеля содержат 0,3—1,8% эфирного масла, 11—21% горечей, называемых общими смолами. Компонентами этих “смол” являются кислоты: гумулон, когумулон, адгумулон и другие, горькое вещество лупулин, сесквитерпены. Кроме того, соплодия содержат валериановую и гумуленовую кислоты, следы алкалоидов (алкалоид хумулин), холин, дубильные вещества (3,5%). Фенольные соединения представлены флавоноидами (кемпферол, кверцетин и их гликозиды, лейкоцианидин, лейкодельфинидин), кумаринами, фенольными кислотами.
Мужские соцветия хмеля представляют собой сильно разветвленную метелку, на которой по одиночке на коротких цветоножках расположены мелкие цветки. На одном мужском растении находится очень большое количество цветков. Мужские цветки начинают цвести на 3-4 дня раньше женских (В.Н. Виноградов, Л. Сергеев, 1977). Свежесобранный хмель содержит большое количество воды (около 75%), хмелевые смолы, дубильные вещества и эфирное масло, участвующие в технологическом процессе при производстве пива и являющийся ценным сырьем используемым в медицине, косметологии и идругих отраслях промышленности (В.И. Вержбицкий, В.Д. Полищук, 1975).
В литературе есть данные согласно которым до 1950 года были известны только две составляющие группы хмелевых смол, первоначально считавшиеся химическими индивидуумами (В.М. Бондаренко 1959), а именно альфа-горькая кислота, или гумулон и бета-горькая кислота или лупулон.
Сбор хмеля начинается, как только шишки закрываются и приобретают желто-зеленую окраску, а также клейкость и аромат. В зависимости от месяца произрастания наиболее благоприятное время для сбора шишек – август − сентябрь. Ощипанные шишки содержат много воды, поэтому их сушат (обычно в специальных сушилках, можно и в печи) при температуре никак не выше 50°С.
Однако А.Б. Остроменьский (1979) указывает на быстрое снижение качества хмеля после наступления технической зрелости, в связи, с чем рекомендует сжатые сроки уборки (10-15 суток).
К такому же выводу пришли В.М. Шуляр, И.Г. Рейтман, С.А. Зинчинко (1980) которые исходя из результатов своих исследований рекомендуют убирать хмель в течении 6-8 суток.
У большого числа сортов хмеля цианидины, или цианигены во много раз преобладают над делфинидином или делфинигеном .
Было установлено Е.П Либацкий (1993), что хмель содержит катехин, эпикатехин и их полимеры. По данным Роллмана (1966) катехин является вторым компонетом основного бифлавоидного антоцианогена хмеля.
Хмелевое эфирное масло придает хмелю характерный аромат, это сложная смесь углеводородов и кислородсодержащих соединений.
С помощью газовой хроматографии постепенно удалось идентифицировать большое число компонентов хмелевого эфирного масла. По данным Лященко (Н.И. Ляшенко, 1977) их насчитывается около двухсот.
Углеводородная (терпеновая) фракция составляет от 40 до 80% хмелевого эфирного масла. Как правило, половина этой фракции - это монотерпены, остаток – главным образом секситерпены. Основной монотерпен- это мирцен, основные сексвитерпены – кариофилены, гумулен и фарнезен. Образование и качественный состав хмелевого эфирного масла также как и горьких веществ является генетическим свойством отдельных сортов хмеля (F. Drawert, J Beier, J Beier, 1973).
По некоторым данным A.H. Burgess (1967) мирцен придает пиву резкий запах и жесткий вкус, в то время как гумулен и кариофилены придают пиву благородный аромат. Соотношение кариофиленов, гумулена и фарнезена зависит у одного и того же сорта хмеля от района его произрастания (Д.А. Гарбузова, 1959).
В состав кислородсодержащей фракции входят спирты, альдегиды и сложные эфиры спиртов.
Основной, с технологической точки зрения несущественной частью хмелевых шишек является клетчатка (целлюлоза). Из других высокомолекулярных полисахаридов хмель содержит от 12 до 14% пектина. Из растворимых сахаридов в сухом веществе хмеля содержится: 0,5% фруктозы, 0,4% глюкозы, 0,5% сахарозы Б.В. Лесик, И.Г. (Рейтман, В.М. Шуляр, 1983).
В хмеле были обнаружены эстрогенный гормон (от 2 до 30 мг на 100 грамм хмеля) и некоторые витамины, а именно тиамин, биотин, пиридоксин, пантотеновую и пантотеновую кислоты. По содержанию токоферолов (витамина Е) хмель превосходит зародыши пшеницы служащие сыръем для получения токоферолов. Если в зародышах пшеницы их содержание примерно 30 мг %, то по данным Ежова И.С. в зависимости от сорта оно варьирует от 18 до 71 мг%. Кроме токоферолов в хмеле содержатся водорастворимые витамины: С, В>1>, В>3> , В>6>, РР и Н (А.Ю. Жвирблянская, В.С. Исаева, 1979). Химический состав по некоторым данным в различных частях растения неодинаков. Установлено, что содержание горьких веществ в шишках хмеля уменьшается от верхних частей растений к нижним, больше всего их содержится в шишках верхней части растения, меньше – в шишках средней части растения и еще меньше в нижней части.
Режим сушки для сохранения качеств хмеля, как и своевременная уборка, имеет первостепенное значение. Особенно осторожно следует обращаться с чересчур сырым хмелем, при сушке которого можно потерять хмелевое масло, которое легко испаряется. Хмелевая мука буреет и разрушается уже при 37°С. Высушенный хмель содержит 10…12% влаги. Для хранения его упаковывают в мешки (желательно из джута) или прессуют.
Теперь о качестве хмеля. У хорошего хмеля - однородные закрытые шишки среднего размера зеленого или желто-зеленого цвета. Лепестки шишек нежные, с приятным ароматом, богаты хмелевой мукой. Когда у шишек явно ощущается запах чеснока, то хмель плохого качества. Если разломить шишку и провести по тыльной стороне руки, то на руке останется след, образуемый лупулином. Сжатый в руке хмель не рассыпается (он склеивается), причем не производит ощущения влажности. Конечно, недопустимо в собранном хмеле присутствие заплесневелых шишек, листьев и стеблей растения, а также разных посторонних предметов, как растительного, так и животного происхождения. (В.И. Вержбицкий, В.Д. Полищук, 1975).
Химический состав хмеля
Показатели в %: Влажность − 10-11; Общие смолы − 10-25; Эфирные масла − 0,4 – 2; Липиды и воска − около 3;Азотистые вещества − 12-22; Полифенольные вещества − 4-14;Углеводы 2-4; Минеральные вещества − 7-10 Целлюлоза − 10-17.
Состав хмеля в сухом виде имеет следующее процентное содержание:
горьких веществ 18,5%;
хмелевого эфирного масла 0,5%;
дубильных веществ 3,5%;
белка около 20%;
минеральных веществ 8%.
Остальное, это целлюлоза и другие вещества, не имеющие особого значения для производства пива. Из общего состава наибольший интерес и исключительную ценность представляют горькие вещества, хмелевое масло и полифенольные (дубильные) вещества. (Н.И. Ляшенко 1976 )
Полифенольные вещества хмеля играют важную роль в защите горьких веществ от окисления и не позволяют образовываться комплексным соединениям. Так же их преимущество в антибиотических свойствах и придании вяжущего вкуса. В процессе производства пива полифенолы способствуют осаждению белка сусла, что благоприятно сказывается на его осветлении. Но вместе с тем отрицательными свойствами полифенольных веществ является то, что с солями железа и при окислении они образуют соединения темного цвета, а так же могут послужить причиной образования мути в пиве. Не смотря на это присутствие полифенольных веществ в пиве очень желательно из-за положительного влияния на создание характерного вкуса пива. (З.А. Аркадьева, А.М. Безбородов, И.Н. Блохина 1989).
Исходя из требований к качественному пиву при его приготовлении, необходимо содержание в используемом хмеле не менее 4,5% полифенолов. Но в этом случае так же учитывается, что при слишком большем процентном содержании у приготовляемого пива может появиться неприятная горечь. Если используется хмель с высоким содержанием полифенольных веществ, то рекомендуется обработать его перед использованием в течение 2 мин. кипяченой водой (А.Б. Остроменьского1979).
Хмелевое эфирное масло придает хмелю присущий ему специфический аромат. Под ним подразумевается от 200 до 250 различных эфирных веществ, легко улетучивающихся при кипячении и придающих пиву желательный ароматный оттенок, зависящий от типа пива. (Н.И Ляшенко, 1977).
Различают два основных вида хмеля: горький и ароматический. В пивоварении используют преимущественно женские соцветия ароматического хмеля – хмелевые шишки, содержащие лупулин. В состав последнего входят ароматические и горькие вещества.
Горькие хмелевые вещества включают [pic]- и [pic]-кислоты. мягкие [pic]-, [pic]- и твердые смолы. Содержание [pic]-кислот в зависимости от сорта хмеля может достигать 16 %. Наиболее ценные для пивоварения производные [pic]-кислот – изосоединения обеспечивают около 90 % горечи пива. (И.Г. Рейтман 1979)
Ароматические вещества представлены в основном эфирным маслом, содержание которого колеблется от 0,3 до 2 %. Важная составная часть хмеля дубильные вещества, количество которых достигает 3 %.
По назначению хмель разделяют на две группы: тонкие сорта с содержанием горьких веществ около 15 % и [pic]-кислот от 3 до 5 %, используемые для производства пива по классической технологии, и грубые сорта с содержанием горьких веществ более 20 %, предназначенные для изготовления порошков, гранул и экстрактов. В пивоварении используют высушенные хмелевые шишки, молотый, гранулированный или брикетированный хмель, а также различные хмелевые экстракты. Исследованиями Б.В. Лесик, И.Г. Рейтмана, В.М. Шуляра (1983) установлено, что максимальное количество альфа - кислот в хмеле находилось в период технической зрелости. К аналогичным выводам пришли F. Drawert, J. Beier, J. Beier, (1973) которые установили что в этот период содержание альфа - кислот практически постоянное.
Ляшенко Н.И., и Кулинич М.А. (1976) изучили динамику накопления отдельных компонентов эфирного масла. Ими было доказано, что в начале образования эфирного масла его компоненты были представлены главным образом окисленными продуктами, затем фракция углеводородов превышало кислородсодержащую
Хмель и хмелепродукты следует хранить в сухом, темном и охлажденном помещении с температурой от 0 до 2 °С и относительной влажностью воздуха не выше 70 %.(В.М. Бондаренко, 1959).
Ферментные препараты. Используют при применении более 20 % несоложеного сырья в количестве от 0,001 до 0,075 % к массе перерабатываемого сырья.
Применяют амилолитические (Амилосубтилин Г10х, Амилоризин Пх и др.), протеолитические (Протосубтилин Г10х), цитолитические Цитороземин П10х.
Целлоконингин П10х и др. ферментные препараты, а также их смеси в виде мультиэнзимных композиций.
Амилолитические препараты применяют при затирании при повышенном количестве несоложеного сырья и низком качестве исходного сусла. Они существенно повышают выход экстракта и улучшают качество сусла.
Протосубтилин Г10х используют при повышенных количествах несоложеного сырья и для улучшения качества сусла из некачественных солодов, а также для ликвидации коллоидных помутнений в пиве.
Цитолитические препараты повышают выход экстракта за счет гидролиза некрахмальных полисахаридов, в основном гемицеллюлозы. Одновременно повышаются качество сусла и стойкость пива.
Наиболее перспективным средством является применение мультиэнзимных композиций (МЭК), которые, позволяют сохранить высокое качество «Жигулевского» пива при использовании до 60 % несоложеного сырья.
Дубильные вещества хмеля, относящиеся к группе катехинов, обусловливают терпкость вкуса сусла, его прозрачность и интенсивность окраски.
Эфирное масло хмеля, представленное смесью ароматических углеводородов и терпенов, играет определенную роль в образовании аромата пива, несмотря на то, что в процессе кипячения сусла большая часть эфирного масла улетучивается.
Для улучшения качества пива и полного использования экстрактивных веществ хмеля разработана технология производства молотого брикетированного хмеля, позволяющая уменьшить расход хмеля на 15%. Применяют так же и хмелевые экстракты в соотношении 1:1. (В.М. Бондаренко, 1959).
3 Выделение чистой культуры дрожжевых грибов
В зависимости от программы исследований выбирают тот или иной метод отбора образцов, позволяющий либо только обнаружить и количественно учесть дрожжевые организмы в анализируемом субстрате, либо обнаружить для накопления их биомассы. В разных областях научных исследований и каждой отрасли промышленности имеются свои указания относительно деталей правильного отбора проб для микробиологического анализа. (И.П. Бабьева, В.И. Голубев, 1979).
Поверхность твердого тела. Ее исследуют путем получения смыва, отпечатка или соскоба.
Смыв производят стерильной водой непосредственно с объекта, помещая его в сосуд или же при больших размерах объекта пользуясь ватными или марлевыми тампонами. Такие тампоны затем опускают в суспензионную жидкость, встряхивают и делают высев. Недостатки этого метода заключаются в том, что его, во первых, трудно стандартизовать (разные люди прикладывают разные усилия при смыве ) и во вторых, вата активно сорбирует клетки микроорганизмов и суспензия получается обедненной. Для количественного учета эта техника непригодна. Несмотря на указанные недостатки ,различные методы смыва остаются на более распространенными в области медицинской и санитарной микробиологии, а также при изучении эпифитной флоры зеленых растений. В последнем случае используют непосредственный смыв без тампонов путем нанесения целых листьев или их частей в колбы с водой. При сравнительных исследованиях из листа вырезают пластинки стандартной площади, чтобы можно было сделать пересчет числа микроорганизмов на 1см 2 . листья или вырезанные из них пластинки встряхивают в колбе с водой 10 минут на качалке, а затем делают. (В.Г. Бабицкая, И.В. Стахеев 1977).
Растирание материала, которое иногда рекомендуют, не всегда желательно, так как при этом освобождаются токсические вещества, фитонциды, которые могут оказать губительное действие на микробные клетки.
Метод смыва с поверхностей применяют при исследовании таких объектов, как плоды и овощи, зерно и сметана, мясо и шкуры и тому подобное, а также с оборудования. (В.А. Быков и др. 1987).
Соскоб производят стерильным скальпелем непосредственно в сосуд со стерильной водой. Суспензию перед посевом либо встряхивают 10 минут, либо обрабатывают 5 минут на микроразмельчителе тканей.
Отпечатки приготовляют прямыми или опосредованными методами.
Прямые методы основаны на снятии дрожжевых клеток с исследуемой поверхности различными прозрачными адгезивными материалами: Коллодиевой пленкой бесцветным лаком, липкой целлофановой лентой, полиэтиленовой пленкой, смазанной клеящим веществом. Полученные отпечатки просматривают под микроскопом опуская пленки в капли воды или лактофенола на предметном стекле. (В.Г. Бабицкая, И.В. Стахеев 1977).
Липкой лентой можно снимать и предварительно нанесенную на поверхность объекта тонкую агаровую пленку. Полоску ленты с агаром и прикрепившимися к нему дрожжевыми клетками, рассматривают затем под микроскопом без проращивания. Методы получения отпечатков имеют некоторые общие недостатки: далеко не все клетки снимаются с исследуемой поверхности; при густой обсемененности клетки могут располагаться слишком близко друг от друга и их трудно учитывать. При получении отпечатка с последующим проращиванием исследуемый объект прижимают к поверхности плотной питательной среды, а затем его удаляют, и чашки со средой ставят в термостат. Таким образом удается хорошо наблюдать плотность заселения и характер распределения дрожжей на поверхности листовой пластинки. Если объект большого размера, то поступают наоборот: к нему прижимают приготовленную среду, пользуясь методом агаровой колбаски. Колбаски делают из разных питательных агаров, запечатывая их стерильно в пергаментную обертку. Срезая последовательно круглые ломтики, их 4 размещают в стерильные чашки Петри и проращивают во влажной камере. (И.П. Бабьева и В.И. Голубев1987).
Отпечатки можно получать с помощью мягких пластичных материалов, таких как бархат, замша, вельвет из которых делают круглые подушки - репликаторы. Лучше всего использовать - бархат велюр, белый или бледно желтый (другие краски могут быть токсичны).Бархат первоначально кипятят, режут круглые куски и приклеивают их к алюминиевым дискам такого размера чтобы они помещались в чашку Петри. (А.Ю. Жвиблянская, В.С. Исаева, 1979).
Стерилизую завернутыми в бумагу сухим жаром при 160оС 1 ч. Перед использованием поверхность бархата смачивают жидкой питательной средой и прикладывают его к исследуемому объекту на несколько секунд. Затем не сдвигая! Осторожно отнимаю и переносят в чашку Петри. Отпечатки делают на серии чашек с одной или разными средами. После употребления репликаторы стерилизуют в сосудах с водой автоклавированием 20 мин при 120оС, подсушивают и расправляют бархат шпателем. Особенно удобно пользоваться мягкими репликаторами при работе с неровными и шероховатыми поверхностями.
Сыпучие и плотные субстраты. Их берут для анализа в стерильные пергаментные пакеты. Влажные пробы отбирают в стерильные стеклянные банки или новые полиэтиленовые пакеты. Отбор проб ила со дна водоемов производят статометром, или дночерпателем. В других случаях пробы можно брать специальной ложкой, ножем или шпателем, которые предварительно протирают спиртом и обжигают. (С.А. Коновалов, 1962).
При сборе образцов почв для экологического исследования соблюдают специальные правила, гарантирующие репрезентативной выборки.
Прозрачные жидкости и взвеси. Присутствие дрожжей в них можно установить непосредственно под микроскопом или после концентрирования на центрифугах при частоте вращения 2000 об/мин в течении 15-20 мин.
Пробу воды и жидкостей отбирают в стерильные сосуды. Воду из природных водоемов берут специальными приборами-батометрами. Из них воду фильтруют через мембранные фильтры с порами диаметром 1,2 мкм. Далее фильтры либо помещают на поверхность питательных сред для проращивания клеток дрожжей, либо окрашивают и наблюдают под микроскопом. Можно брать два фильтра: один для проращивания и окраски, а другой (нижний) для контроля на пропускание.
Масла и эмульсии, включая сливочное масло и мороженое, можно также исследовать методом мембранных фильтров после обработки их эмульгаторами. Жидкости и взвеси необходимо анализировать вскоре после отбора проб, а при невозможности этого хранить в холодильнике не более 1-2 сут, так как далее первоначальное количество дрожжей в них может существенно измениться. (М.И. Ратнер и Каннель Э.С.).
Воздух. Методы анализа воздуха основаны либо на осаждении аэрозолей, либо на фильтрации его через жидкости или твердые фильтры.
Метод Коха основывается на свободном оседании микробных аэрозолей на поверхность питательной среды под влиянием гравитационных сил. Чашки со средой оставляют открытыми на 5-15 мин, а затем закрывают и помещают в термостат. Этот метод используют для обнаружения дрожжей в воздухе закрытых помещений при кратковременной экспозиции чашек. В открытых местах его использованию мешают горизонтальные потоки воздуха.
Все другие методы определения микроорганизмов в воздухе основан на принудительном его токе, который создается разными способами.
Для санитарно-микологического контроля окружающей среды на предприятиях по производству белково-витаминных препаратов и кормовых дрожжей количественный учет дрожжей – продуцентов рода Сandida рекомендуется проводить щелевым методом на сусло-агаре и МБС – метабисульфитном агаре (МПА + 0,2% метабисульфита натрия ) с добавлением биомицина в количестве 100000 ед/л. Рост продолжается 48ч при 37°.(С Фениксова Р.В. 1973).
Для фильтрации воздуха через жидкости используют прибор Киктенко, основанный на осаждении микробных клеток в улавливающей жидкости, которую затем переносят по 0,1 – 0,3 мл на плотную среду и проращивают.
Общий принцип посевов заключается в том, что образец превращают в такое состояние, когда он может быть серийно разведен, чтобы сделать из него высев или сразу в чашки, или перевести клетки сначала на мембранные фильтры. (Коновалов С.А. 1962)
В качестве суспензионных жидкостей используют стерильную водопроводную воду, в которую иногда добавляют поверхностно-активные вещества (например, Твин-80, 1капля на 0,5 л), 0,5%-ный раствор NaCl в дистиллированной воде (при выделении психрофильных дрожжей).
Высев на плотные питательные среды из подготовленной суспензии делают пипеткой, внося в каждую чашку по 0,5 мл или по одной капле измеренного объема. Чашек берут всегда не менее трех для каждого разведения, чтобы получить среднее число колоний на одной чашке.
После посева чашки инкубируют 24 ч в обычном положении, чтобы агар адсорбировал жидкость, а за тем перевертывают во избежание попадания на поверхность капель конденсата с крышки.
При инкубировании посевов большое значение имеет поддержание определенной температуры. Преобладающее число видов дрожжей относится к группе мезофильных микроорганизмов с температурными границами роста от 2 – 5 до 30 – 37°С и оптимумом при 26 – 28°С. Среди дрожжей нет истинных термофилов, для роста которых требуются температуры выше 50°С. При выращивании дрожжей при температуре 40 – 45°С необходимо добавлять в среду олеиновую кислоту.( Жвирблянская А.Ю., Исаева В.С.)
Подбор температурных условий при выделении дрожжей зависит от источника выделения и целей исследования. Из теплокровных животных и из различных органов человека и связанных с ним субстратов дрожжи выделяют при 37°С, если хотят найти патогенные формы, и при 28°С в случае поиска сапрофитных видов. Если дрожжи растут при 37°С, то требуется соблюдать осторожность, так как среди них могут быть патогенные – Cryptococcus neoformans или Candida albicans (=Syringospora albicans).
Посевы из материала, где предполагается наличие психрофильных дрожжей, инкубируют в холодильнике при температуре 4 – 5°С.( Коновалов С.А. 1967).
Сроки инкубирования непосредственно зависят от температуры. При 37°С инкубируют не более 4, а в холодильнике не менее 14 сут. Если дрожжи дают визуально заметный рост при 4 – 5°С в течение 7 – 10 дней, то их относят к истинным психрофилам при условии, что выше 20°С они не растут. Температурный оптимум таких дрожжей находится обычно в диапазоне от 10 до 15°С. Психротолерантные дрожжи вырастают при 5°С в течение 2 – 3 недель, а психрофобные при температуре ниже 30°С не растут совсем. В посевах из почвы, инкубируемых при низких температурах, удается учесть в 2 – 3 раза больше дрожжей, чем при 28°С, так как росту дрожжевых колоний при этом не мешают грибы с быстро распространяющимся мицелием. Учет опытов в этих случаях следует производить дважды – через две недели и через месяц.
Стандартные полноценные питательные среды. Эти среды применяют с целью наиболее полного учета и выделения большинства видов дрожжей. Наиболее широко используемой полноценной средой для выращивания дрожжей является солодовое сусло. В его состав входят глюкоза, фруктоза, сахароза, мальтоза, мальтотриоза и мальтотетраоза, а также небольшое количество пентоз – арабиноза, ксилоза и рибоза. Азотные компоненты составляют 6 – 7% сухих веществ (СВ), среди них аммонийного азота 2,18 – 2,44 мг на 100 мл. В сусле имеются аминокислоты, все основные витамины группы В и минеральные вещества, содержание которых зависит от используемой воды.( Бабьева И.П., Голубев В. И.).
Сусло получают с пивоваренных заводов неохмеленное, после фильтрации. Его разводят водопроводной водой до концентрации 6 – 8% СВ.
Для приготовления сусла в лаборатории используют ячменный солод крупного помола с высокой осахаривающей способностью. В 1 л воды вносят 250 г солода и нагревают до 50°С. Через 30 мин постепенно поднимают до 62,5 – 63°С и не снижают до исчезновения реакции на крахмал (йодная проба). Полученное сусло отделяют от дробины путем фильтрации через марлю и вату, разбавляют водой до нужной концентрации, разливают по колбам и стерилизуют при 112°С 30 мин. Если рН ниже 5,5, то сусло подщелачивают 10%-ным раствором соды или едкого кали до получения рН 5,6 – 6,0. Сусло очищают от примесей кизельгуром или отстаиванием в холодильнике с фильтрацией. Для приготовления плотных сред к суслу перед стерилизацией добавляют 2% агара или 20% желатины.( Быков В. А.).
Сусло-агар можно приготовить из сухого солодового экстракта, 20 г порошка растворяют в 400 мл горячей дистиллированной воды, содержащей 12 г агара, и стерилизуют при 121°С 15 мин.
Из синтетических сред наиболее часто для дрожжей используют агар Сабуро, называемый также глюкозо-пептонной средой, со следующим составом(в г на 1 л водопроводной воды): глюкоза 40, пептон 10, агар 20.
Глюкозо-аммонийная среда содержит (в г на 1 л водопроводной воды) следующие вещества: Глюкоза − 20,0; (NH>4>)> 2>SO>4> − 5,0; KH>2>PO>4> − 0,85; K>2>HPO>4> − 0,15; MgSO>4> − 0,5; NaCl − 0,1; CaCl>2> − 0,1; Агар − 20,0;
Для обогащения факторами роста к этим средам добавляют иногда дрожжевой (0,2%) и мясной (0,3%) экстракты и виноградный сок (3%).
Дифференциальные среды. Их используют при выделении дрожжей из субстратов, сильно загрязненных другими микроорганизмами. Для подавления роста сопутствующих микроорганизмов к указанным выше питательным средам добавляют различные ингибиторы. Рост большинства бактерий и актиномицетов подавляется при низком значении рН среды, поэтому чаще всего среды для выделения дрожжей подкисляют до рН 4,5 путем добавления к ним органических кислот. Для синтетических сред наиболее применима соляная кислота, для сусловых молочная, лимонная или винная. Для подкисления заводского солодового сусла (6 – 8% СВ) обычно требуется 3 – 4 мл/л концентрированной молочной кислоты. Кислоты добавляют в жидкую или расплавленную агаровую среду после стерилизации, непосредственно перед засевом или перед разливкой в чашки Петри. Все дрожжи, кроме Schisosaccharomyces pombe (рН 5,45), растут при рН до 2,5. Если брать 3% агара, то среда застывает при рН 4,8. (Градова Н. Б).
Вместо кислот используют также антибиотики широкого спектра действия: стрептомицин (80мг/л или 100 ел/мл), пенициллин (20-100 ед/мл), левомицетин (50 мг/л) и др. Их можно добавлять в среду порознь и в комплексе. Например, против кислотоустойчивых бактерий применяют следующие смеси антибиотиков: актиномицин 2 мг/л +ауреомицин 50 мг/л; пенициллин 60 ед/мл +стрептомицин 100 ед/мл; левомицетин (хлорамфеникол) 20 мг/л +строптомицинсульфат 20 мг/л +хлортетрациклин солянокислый 100 мг/л.
Для отделения сахаромицетов от других дрожжей добавляют 2,5% этилацетата и рН до 4,0 доводят уксусной кислотой. Затем чашки герметизируют. При этих условиях колонии сахаромицетов появляются первыми.
Росту дрожжей на питательных средах при высеве из исходного материала зачастую препятствуют грибы с широко распространяющимися по поверхности субстрата мицелиальными колониями. Они имеют общие с дрожжами потребности в источниках питания, устойчивы к низким значениям рН среды и нечувствительны к действию указанных выше противобактериальных антибиотиков. Для ограничения роста микромицетов в среду добавляют специфические вещества: дифенил (0,005-0,01%), бычью желчь (0,25-0,5%), теллурат калия (0,05-0,15%), пропионат натрия (0,15-0,25%), – или некоторые красители: бром-крезоловый пурпурный (0,0025% или 2,5 мл/л 1% раствора), бенгальский розовый (0,003%), кристаллический фиолетовый (0,001%).( Грин Д.).
Элективные среды. Их применяют для дрожжей из специфических мест обитания.
Осмофильные дрожжи, обитающие в природе в гнездах диких пчел (в меде), обнаруживаемые в производстве сахара и при порче меда или других продуктов с большим содержанием сахара, выделяют на средах с высоким осмотическим давлением: на медовом и осмофильном агарах.
Состав сред: медовый агар: 70% меда в водопроводной воде и 2% агара; синтетический «медовый» агар: 60 г глюкозы, 0,5 г дрожжевого экстракта, 2,5 г агара, 100мл воды; осмофильный агар: б сироп, содержащий 35 массовых частей сахарозы и 10 частей глюкозы, добавляют агар и стерилизуют 20 мин при 112°. Повторное расплавление не рекомендуется.
При выделении осмофильных дрожжей посевы делают на указанные среды и для сравнения – на обычные. Сахар, мед или сиропы растворяют в воде и фильтруют через мембранные фильтры, которые затем помещают для проращивания на агаровые среды. (Жвирблянская А.Ю., Исаева В.С). Почвенные олигонитрофильные дрожжи Lipomyces выделяют на безазотистых средах. Примером такой среды может служить модифицированный агар Эшби (в г 1л дистиллированной воды) : Сахароза − 20,0; K>2>HPO>4> − 0,2; KH>2>PO>4> − 0,1 ; MgSO>4>·7H>2>O − 0,2 ; NaCl − 0,2; K>2>SO>4> − 0,1 ; Агар − 20,0.
Для подавления роста бактерий к этой среде добавляют 80 мг/л стрептомицина. Посев производят комочками почвы: навеску в 100 мг распределяют на две чашки Петри, по 50 комочков на каждую. Для равномерного распределения используют трафарет, который подкладывают под чашку. Учет обрастаний производят через 25-30 сут. инкубирования при комнатной температуре. Результат выражают в процентах обрастания комочков почвы молочно-белыми слизистыми колониями липомицетов. (Коновалов С.А.).
Дрожжевые колонии в посевах учитывают следующим образом. Обратную сторону каждой чашки разделяют чернилами на большее или меньшее число частей – от четырех до шестнадцати в зависимости от густоты посева – и просматривают все колонии на каждой площади с объективом 10× в просвечивающем микроскопе или с бинокулярной лупой в отраженном свете. Описывают все встречающиеся типы колоний в стандартных терминах. Из них готовят препараты и микроскопируют при больших увеличениях. Этот детальный просмотр колоний при первом посеве очень важен, так как при последующих пересевах некоторые признаки, например спорообразование, иногда исчезают. Рекомендуется сразу же делать фотографии или зарисовки. Колонии разных типов нумеруют и просчитывают отдельно.( Фениксова Р.В.).
Учет производят дважды. В первый срок отмечают с обратной стороны чашки все выросшие и просчитанные колонии, а за тем оставляют чашки еще на несколько дней для наблюдения за возможным появлением колоний медленно растущих дрожжей.
Отдельные изоляты (штаммы) получают путем пересева из индивидуальных колоний в пробирки на те же среды, на которые производили первичный посев, но без добавления специфических ингибиторов.( Бабьева И.П., Голубев В. И.).
Чистой микробной культурой называют популяцию, представляющую собой потомство одного вида микроорганизма. Каждый новый изолят носит название штамма, которому присваивают буквенное или номерное обозначение.
Расами называют производственные штаммы одного вида дрожжей, различающихся между собой по степени проявления физиологической активности.
В генетических исследованиях пользуются так называемыми клонами – чистыми культурами, полученными от одной споры или гаплоидной клетки. (Бабьева И.П., Голубев В. И.).
Существуют прямые и непрямые методы получения чистых культур дрожжей. Первые основаны на выделении одной клетки или споры под непосредственным контролем через микроскоп. Во втором случае используют косвенные приемы для разделения клеток.
Капельный способ Линдера. Суспензию дрожжей разбавляют жидким суслом до концентрации ≈ 100 клеток в 1 мл и стерильным чертежным пером наносят мельчайшие капельки на необезжиренное покровное стекло, простерилизованное фламбированием в пламени газовой горелки. Капельки располагают в определенном порядке, обычно по пять капель в два ряда, т. е. всего 10 капель на стекле. Затем быстро опрокидывают стекло над влажной камерой, которую запечатывают минеральной смазкой. Все капли немедленно просматривают под микроскопом и отмечают те из них, которые содержат по одной единственной клетке. Если все капли содержат по нескольку клеток, то увеличивают разбавление суспензии и процедуру повторяют. После трех – четырехдневного инкубирования, когда отмеченные единичные клетки образуют микроколонии, последние переносят стерильной иглой или полоской стерильной фильтровальной бумаги в жидкую среду и размножают.( Бабьева И.П., Голубев В. И.).
Метод Линдера в видоизменении Надсона. Чистое покровное стекло проводят трижды через пламя горелки и края его обводят мастикой (смесь равных частей парафина и вазелинового масла). На центральную часть стекла наносят полоску прозрачной среды ч 10% желатины или 0,5 агара. В теплую и еще не застывшую среду вносят иглой суспензию дрожжей такого разведения, чтобы в каплю попало всего несколько клеток. Стекло помещают во влажную камеру и рассматривают препарат при малом увеличении микроскопа. (Булгаков Н.И.).
Находят ориентиры, которыми могут быть частички взвеси, пузырьки воздуха или дефекты стекла, и вычерчивают карту с расположенными по отношению к ориентирам одиночными клетками дрожжей. Через каждые 10-20 ч препарат повторно исследуют, зарисовывая все изменения. Когда отмеченные клетки разрастаются в микроколонии, покровное стекло перевертывают на предметное и под контролем глаза при малом увеличении микроскопа переносят иглой материал в пробирки. ( Булгаков Н.И.).
Метод Линдера, упрощенный Вучковичем. Видоизменение Вучковичем метода Линдера сводится к тому, что капельки суспензии, содержащие 3-4 клетки дрожжей, снимают петлей, которой предварительно захватывают стерильную среду, и переносят штрихом на поверхность плотной среды. Через некоторое время появляются микроколонии, число которых на одном штрихе должно соответствовать количеству исходных клеток в отмеченной капельке.
Из этих колоний пересевом выделяют чистые культуры. Таким способом можно сразу получить несколько одноклеточных культур за короткое время.
Выделение спор дрожжей при помощи микроманипулятора. К использованию микроманипулятора прибегают главным образом при необходимости изолировать споры из асков, так как вегетативные клетки легко повреждаются при микроманипулировании.
Аски разрывают либо механически прикосновением игл микроманипулятора, либо заранее обрабатывая суспензию препаратом ферментов (например, из пищеварительного тракта виноградной улитки Helix pomatia), из лизирующих клеточную стенку дрожжей.
Для работы с микроманипулятором требуются специальные стеклянные микроиглы и влажные камеры. (Палагина Н. К.).
В эту группу включаются методы, основанные на разделении клеток в питательных средах и использовании специфических биологических особенностей отдельных видов для создания преимущественных условий для их роста.
Метод поверхностного посева на агаровые среды. Посевы производят либо из суспензии пипеткой, либо петлей по принципу «истощающего штриха».
Каплю суспензии, содержащей дрожжевые клетки наносят на поверхность застывшей подсохшей среды в чашке Петри. Стерильным стеклянным шпателем равномерно распределяют каплю по поверхности. Этим же шпателем можно еще засеять 2-3 чашки на случай, если в первой будет очень густой рост колоний. Процессы выделения чистой культуры заканчивается пересевом из отдельной, выросшей изолированно колонии в пробирку. Контролем чистоты выделенной культуры служит однородность клеток под микроскопом и однотипность колоний на чашке при последующем рассеве.
Метод рассева на поверхности агаровых сред можно применять как при работе с уже имеющимися культурами при проверке их чистоты, так и при первичном выделении дрожжей из любого субстрата. С целью повышения возможностей избирательного выделения культур дрожжей определенного вида, для рассева используют селективные среды, а при культивировании создают особые температурные условия. (Попова Т.Е., Попова Е.В.).
Для выделения дрожжей родов Brettanomyces и Lipomyces используют их устойчивость к антибиотику актиноиду, добавление которого в среду в концентрации 100-200 мг/л подавляет рост большинства видов других дрожжей.
Выделение чистых культур баллистоспоровых дрожжей. Баллистоспоровые дрожжи легко получить в чистой культуре, используя их способность отбрасывать споры на значительное расстояние. Если после посева на поверхность агаровой среды налить расплавленный агар в крышку чашки Петри и инкубировать ее в перевернутом положении, то через некоторое время на нижней пластинке появятся колонии в результате прорастания отстрелявшихся баллистоспор.
Поддержание и хранение чистых культур дрожжей
Длительное поддержание чистых культур микроорганизмов необходимо как при проведении научно-исследовательских работ, так и в производстве и при хранении в коллекциях.
Из-за различий биологических свойств видов невозможно использовать с равноценными положительными результатами один общий способ хранения для разных культур дрожжей. Большой опыт по хранению культур микроорганизмов, в том числе и дрожжей, накоплен сотрудниками крупных национальных коллекций, в которых имеется возможность проверять и оценивать разные методы хранения применительно к широкому набору дрожжевых организмов.
Наиболее широко применяемый способ – это поддержание культур путем их периодических пересевов. В последние два десятилетия получили распространение также методы хранения микробных культур под минеральным маслом и лиофильная сушка. Так как эти три метода применяются уже много лет, то имеется возможность сравнительной оценки их пригодности для хранения разных видов дрожжей. Другие, менее широко используемые или недавно разработанные методы можно рекомендовать лишь для проверки с обязательным дублированием культур, которые поддерживаются обычными способами. (Семихатова Н. М., Белова М. Ф., Лозенко Л. Д.).
Периодические пересевы
Обычно культуры поддерживают, пересевая их на агаровых средах в двойной повторности. Одна пробирка, которую после засева совсем не открывают, служит контрольной, а из второй по мере надобности делают отсевы.
Частота пересевов. Сроки пересевов определяют для большинства культур дрожжей скоростью высыхания среды. Она зависит от температуры и влажности помещения, где хранят пробирки. В голландской коллекции*, насчитывающей более 6000 штаммов дрожжей, культуры хранят в специально предназначенных для этих целей, в постоянно проветриваемой комнате, где температура поддерживается зимой 18°С, а летом 20°С. Частота пересевов при этих условиях – каждые 5-7мес или пять раз в два года для основной массы культур и более частые для немногих других: например, ежемесячные для Schizosaccharomices japonicas и каждые две недели для Cyniclomyces (=Saccharomycopsis) guttulata.
Промежутки между пересевами можно увеличить за счет более плотного закупоривания пробирок и снижения температуры хранения. Так использование пробирок с завинчивающимися металлическими крышками вместо обычных ватных пробок предохраняет от высушивания, но хуже обеспечивает чистоту сохраняемых культур. Применение вазелинового масла для снижения скорости высыхания культур так же имеет свои недостатки. Поэтому хорошо сделанные ватные пробки(их можно сверху заливать парафином) все же остается лучшим средством закрывания пробирок. Они обеспечивают достаточный газообмен, хорошо предохраняют от микробного загрязнения и легко изготавливаются при помощи специальных машин, которые просты и доступны для любой лаборатории. .( Бабьева И.П., Голубев В. И.).
Ватные пробки, однако, не предохраняют культуры от заражения их микофильными клещами (mites). Для профилактики используют следующий прием. Перед посевами или пересевами культур пробку слегка выдвигают из пробирки и наносят на нее каплю раствора содержащего 10г сулемы, 50мл глицерина, 500мл этилового спирта и 450 мл воды. Затем пробку вдвигают в пробирку и несколько раз проворачивают ее, чтобы смочить внутренние стенки пробирки. В раствор можно добавить какой-либо краситель, для контроля за равномерностью смачивания.
Температура. Если хранение ведется при температуре в пределах 15-20°С , то после пересева пробирки сразу же помещают в коллекционное помещение, за исключением тех культур, которые требуют для роста более высокой температуры. К последним относятся, например, такие виды, как Saccaharomyces castellii и Torulopsis lacctis-condensii которые инкубируют при 30°С, а Candida slooffii, Pityrosporum ovale, P. Pachydermatis, Torulopsis bovina, T. Pintolopesii и Saccharomyces telluris – при 37°С психрофильные дрожжи выращивают и хранят при 3-4°С в холодильнике. Это виды: Candida aquatic, C. curiosa, C. salmonicola и все представители рода Leucosporidium. При низкой температуре после появления хорошего роста можно хранить и все другие дрожжи, за исключением психрофобных видов, ассоциированных с теплокровными животными, и некоторых устойчивых к полиеновым антибиотикам мутантов.
Среды. Во многих лабораториях и коллекциях дрожжи поддерживают и хранят на сусло-агаре. Было показано, однако, что на этой сложной среде при длительном хранении происходит изменение физиологических свойств, характерных для вида, за счет адаптации или стабилизации мутантов. В связи с этим для хранения более пригодна среда следующего состава, (в %):
Глюкоза 4 дрожжевая вода
Пептон 0,5 рН 5,8-6,0
Дрожжевую воду готовят, автоклавируя при 121°С 15 мин суспензию дрожжей (200 г на 1 л водопроводной воды) с небольшим количеством яичного белка. После стерилизации еще горячую воду дважды фильтруют через бумажный фильтр. .( Бабьева И.П., Голубев В. И.).
Пивоваренные дрожжи лучше поддерживать на сусло-агаре или на среде следующего состава (в %): Сусло − 3; Дрожжевой экстракт − 3; Пептон 5; Глюкоза − 1; Агар − 2.
Лучше растут на сусле, чем на глюкозо-пептонной среде, базидомицетовые дрожжи, близкие к головневым грибам.
Липомицеты поддерживают на среде с солодовым и дрожжевыми экстрактами, на которой эти дрожжи лучше сохраняют спорообразующую способность(в г/л.): Глюкоза − 10; Пептон – 5; Сусловый агар – 3; Дрожжевой экстракт – 3 Агар – 20; Водопроводная вода, л – 1.
В некоторых коллекциях дрожжи поддерживают в жидких средах (сусло с дрожжевым автолизатом, пептоном и глюкозой) с пересевами через 4 мес.
Осмотолерантные дрожжи, например Saccaromyces (= Zygosaccaharomyces) rouxii, пересевают на среде с высоким осмотическим давлением, а именно: на сусло-агаре с 50% глюкозы.
Дрожжи родов Brettanomyces и Dekkera сильно подкисляют среду в процессе роста и быстро гибнут, поэтому для их культивирования добавляют в среду 2% СаСО>3 >и делают пересевы через каждые 2 мес.
Существуют также другие способы хранения чистых культур дрожжевых микроорганизмов.
Хранение под минеральным маслом заливка агаровых культур минеральным маслом с целью задержать высыхание и тем самым увеличить сроки пересевов.
Лиофилизация − процесс высушивания под вакуумом из замороженного состояния.
Методы криогенного хранения − замораживание дрожжей производят при разных режимах, включая температуры от − 10 до − 196°С и различные скорости охлаждения.
Хранение на адсорбентах − в качестве адсорбентов используют почву, песок, коалин, селикагель, вату и фильтровальную бумагу. Этот способ хранения не имеет разработанной стандартной техники.( Семихатова Н. М., Малыгина М. В., Володина Т. И.).
2 Глава Собственные исследования
Схема 1 направления исследования
Сбор хмеля и подготовка его к исследованию
↓
Сушка хмеля
↓
Приготовление смыва
↓
Первичный посев
↓
Инкубирование
↓
Микроскопирование колоний
↓
Получение ЧКД
↓
Идентификация полученных культур
2.1 Материалы и методы исследований
Работа проводилась на кафедре биологической и химической технологии Горского ГАУ, т. к. материально – техническая база позволила провести все необходимые исследования. Материалом для проведения исследований явились: дикий хмель и выделенные из него дрожжи.
Работа включала следующие этапы:
выделение штаммов дрожжей;
определение видовой принадлежности выделенных дрожжей.
экономические расчеты.
Приборы и оборудование
В ходе исследований использовали :
Автоклав;
Термостат;
Холодильник;
Шкаф сушильный;
Настольный бокс;
Микроскоп;
Весы ( настольные и аналитические );
Различную химическую посуду;
Питательные среды и реактивы.
Методы исследований
Поверхность твердого тела исследуют путем получения смыва, отпечатка или соскоба
Смыв производят стерильной водой непосредственно с объекта, помещая его в сосуд или же при больших размерах объекта пользуясь ватными или марлевыми тампонами. Такие тампоны затем опускают в суспензионную жидкость, встряхивают и делают высев. Метод смыва с поверхностей применяют при исследовании таких объектов, как плоды и овощи, зерно и сметана, мясо и шкуры и тому подобное, а также с оборудования. Высев на плотные питательные среды из подготовленной суспензии делают пипеткой, внося в каждую чашку по 0,5 мл или по одной капле измеренного объема. Чашек берут всегда не менее трех для каждого разведения, чтобы получить среднее число колоний на одной чашке После посева чашки инкубируют 24 ч в обычном положении, чтобы агар адсорбировал жидкость, а за тем перевертывают во избежание попадания на поверхность капель конденсата с крышки Подбор температурных условий при выделении дрожжей зависит от источника выделения и целей исследования
Определения проводили по следующим ГОСТам :
сухое вещество – высушиванием в сушильном шкафу при температуре 60°С;
гигроскопическая влажность – высушиванием в сушильном шкафу при температуре 100 – 105° С, ГОСТ 1396.3 – 92 (27548 - 97);
«сырой» жир – в аппарате Сокслета, ГОСТ 13496.65;
«сырой» протеин – по методу Къельдаля, ГОСТ 1396.4 (28074 – 89);
«сырая» зола – методом сухого озоления (температура 400 – 4500С), ГОСТ 26226 – 95;
БЭВ – расчетным методом.
2.2 Подготовка питательной среды
Среды для дрожжей и грибов
Для выращивания дрожжей, при выполнении эксперимента мы использовали следующие виды питательных сред.
Среда Сабуро. Основой этой среды является дрожжевая вода. На 1 л водопроводной (недистиллированной) воды берут 80 г прессованных пекарских дрожжей (или 20 г сухих дрожжей), кипятят 15 мин, фильтруют через бумажный фильтр, разливают по флаконам и стерилизуют при 1 атм 20 мин. К 100 мл стерильной дрожжевой воды добавляют 1% пептона, 2% агара,
нагревают до растворения агара, затем добавляют 4% глюкозы (или мальтозы), фильтруют, разливают в пробирки и стерилизуют при 0,5 атм 20 мин. После стерилизации среду в пробирках скашивают. Выращивание длится 48 ч при 22°С. Среду можно готовить и не на дрожжах, а из-обычной 1% пептонной воде.
Жидкая среда Сабуро отличается от описанной выше тем, что не содержит агар-агара. Среду разливают в колбы по 150—200 мл, стерилизуют так же, как описано выше. Эта среда употребляется главным образом для получения гомокультуры.
Пивное сусло-агар. Неохмеленное пивное сусло — хорошая среда для некоторых молочнокислых и уксуснокислых бактерий, дрожжей, плесневых грибов и других представителей гетеротрофных микроорганизмов, использующих сахара в качестве источника углерода и энергетического материала. В сусле содержатся аминокислоты, элементы нуклеиновых кислот, витамины (в основном группы В), безазотистые органические кислоты, минеральные соли, большое количество углеводов (до 20%, из которых 80% составляет мальтоза), т. е. все, что необходимо для развития наиболее требовательных сапрофитных микроорганизмов.
Сусло готовят следующим образом. 250 г размолотого солода заливают 1 л водопроводной воды, нагревают до 48—50° и поддерживают эту температуру в течение получаса, непрерывно помешивая смесь, чтобы избежать образования комков. В последующие полчаса температуру поднимают до 55— 58°С и поддерживают ее на этом уровне до полного осахаривания крахмала, т.е: до тех пор, пока реакция остывшей смеси с йодом будет отрицательной. При указанном режиме происходит также гидролиз белков до аминокислот и полипептидов. Экстракт отфильтровывают через вату или бумажный фильтр. В фильтрате определяют концентрацию Сахаров, пользуясь ареометром Баллинга, градусы (°Б) которого примерно соответствуют процентному содержанию сахара в растворе.
Неохмеленное пивное сусло разводят водопроводной водой до содержания сахара 7—8° по Баллингу (измеряют сахарометром) и стерилизуют в бутылях при 110°С 10 мин. В таком виде сусло может сохраняться длительное время. Перед употреблением над осадочную жидкость осторожно сливают с осадка. В 1 л стерильного сусла добавляют 18 г агар-агара, нагревают до растворения агара и разливают среду в стерильные пробирки, стерилизуют при 110°С 10 мин. Жидкое сусло после сливания отстоявшейся жидкости с осадка разливают в пробирки или колбы и стерилизуют при режиме, указанном для сусло-агара.
Рисовая среда Левиной. 20 г риса в зернах измельчают в ступке и заливают 500 мл дистиллированной воды, стерилизуют текучим паром 45 мин. Укрывают тепло и оставляет для отстаивания, затем фильтруют через 4 слоя марли. Осадок не отжимают. 20 г агар-агара расплавляют на открытом огне или текучим паром в 500 мл дистиллированной воды, фильтруют через ватно-марлевый фильтр. Фильтрат агара смешивают с фильтратом риса и добавляют дистиллированной воды до 1 л. Стерилизуют при 1 атм (120°С) 20 30 мин. Разливают в чашки Петри, на которые производят прямой посев материала. Чашки с посевом, плотно завертывают в 2 слоя бумаги и помещают при комнатной температуре или при 30°С на 18 ч. Результаты посева рассматривают под малым увеличением микроскопа непосредственно на чашке. Отмечают филаментацию, тип микроколоний (паукообразный, звездчатый, круглый и др.).
Стерилизация питательных сред.
Стерилизация является заключительной операцией при приготовлении любой питательной среды. Питательные среды после разливки их в сосуды чаще стерилизуют нагреванием — термостерилизацией. Перед стерилизацией сосуды (колбы, пробирки) с налитыми в них средами закрывают ватными пробкам предохраняющими их в дальнейшем от заражения микробами из вне.
Стерилизация насыщенным паром под давлением. Такую стерилизацию проводят в автоклаве. Автоклав представляет собой двухстенный металлически котел, герметично закрывающийся крышкой. Между стенками котла находится вода. Стерилизуемые объекты ставят на дно автоклава. Автоклав снабжен манометром указывающим давление пара в котле, выпускным краном для выхода воздуха и пара и предохранительным клапаном, обеспечивающим выход пара при превышении заданного давления.
Автоклав обогревается газом или электричеством. Образующийся при кипении воды пар поступает в котел через отверстия, имеющиеся в верхней части его внутренней стенки, и через выпускной края выходит, вытесняя из автоклава воздух. После полного вытеснения воздуха (при этом выделяется сильная сплошная струя пара) выпускной кран закрывают и в автоклаве постепенно повышается давление. Когда оно достигнет 1 атм (по манометру), подогрев регулируют, чтобы поддерживать давление на одном уровне в течение необходимого времени. При таком давлении водяной пар имеет температуру 120° С.
При этой температуре выдерживают питательные среды (если объем их не более 0,5—1 л) в течение 20—30 мин. При таком режиме стерилизации погибают не только вегетативные клетки микроорганизмов, споры плесеней и дрожжей, но и бактериальные споры. По окончании стерилизации выключают источник нагрева, после того как стрелка манометра снизится до нуля, осторожно открывают выпускной кран, чтобы вытеснить из автоклава пар. Крышку автоклава открывают лишь после того, как он охладится.
Стерилизуют в автоклаве воду, мясо-пептонный бульон, дрожжевой автолизат, агаровые и другие среды, которые не претерпевают заметных изменений при темпетуре 120° С.
Стерилизация текучим паром. Эта стерилизация бывает дробной, или последовательной. Она применяется чаще для питательных сред, которые могут заметно изменять свои свойства при стерилизации в автоклаве, например молоко, среды, содержащие сахара, желатин.
Для стерилизации используется аппарат Коха (кипятильник Коха). Он представляет собой металлический цилиндр, покрытый изоляционным материалом, с двойным дном и неплотно закрывающейся крышкой, снабженной термометром. На дно цилиндра наливается вода. Над водой располагается металлическая подставка с отверстиями для прохождения пара, на которую помещают стерилизуемые питательные среды.
Вода в аппарате нагревается газом или электричеством до 100°С. Образующийся пар (текучий), прогревает стерилизуемые материалы, выходит через специальное отверстие и неплотности крышки.
Стерилизация производится дробно — в три приема три дня подряд по 30 мин ежедневно. Повторная стерилизация, вызывается тем, что при температуре 100° гибнут не все споры бактерий. В промежутках между нагревами (каждый — раз в сутки) питательная среда выдерживается в термостате при 25° С. За это время оставшиеся живыми споры прорастают в вегетативные клетки, которые и уничтожаются последующим нагревом при 100° С.
Холодная стерилизация (фильтрация). Метод холодной стерилизации применяется для жидких сред, которые не выдерживают нагревания.
Способ заключается в фильтровании сред через специальные мелкопористые бактериологические фильтры, задерживающие микроорганизмы (ультромикробы проходят).
Фильтры изготовляются из различных материалов из фарфоровой глины, асбеста, нитроклетчатки (мембранные ультрафильтры) и др.
2.3 Выделение дрожжей

Смыв производили непосредственно с шишек хмеля, помещая его в сосуд с водой, встряхивая в колбе с водой 10 мин в качалке, а затем делают высев, образец серийно разводят, чтобы сделать высев сразу на чашке Петри. В качестве суспензионных жидкостей использовали стерильную водопроводную воду, в которую добавляют NаCI (5г на 100мл). Посев «истощающим штрихом» производят петлей: либо, нанося очень густые штрихи, либо прожигая петлю после каждого штриха. (См. рис.). Разные способы посева «истощающим штрихом» для получения отдельных колоний 1, 2, 3, 4, 5, 6 – последовательность нанесения штрихов. На двух последних чашках петлю после каждого штриха прожигают.
Высев производили на плотные питательные среды, внося в каждую чашку по 0,5мл смыва с шишек хмеля. После посева чашки Петри помещали в термостат в течении 24 ч в обычном положении, чтобы агар адсорбировал жидкость, а затем чашки переворачивали, во избежание попадания на поверхность капель конденсата с крышки. Инкубированние проводили при t 37 °С – 48 часов.
Дрожжевые колонии в посевах учитывали следующим образом. Обратную сторону каждой чашки разделяли на 4 части и просматривали все колонии на каждой площади с объективом 10Х количественный учёт численности дрожжей и в единице массы или объёма вычисляли по формуле:
n=абв
а – среднее число колоний в одной чашки Петри;
б – число капель в 1 мл суспензии;
в – степень разбавления образца.
Отдельные изоляты (штаммы) получали путем пересева из индивидуальных колоний в пробирки на те же питательные среды, на которые производили первичный высев.
Перед определением каждую культуру проверяли на чистоту путём микроскопирования и рассева на плотные питательные среды. Из каждой исходной культуры готовили пересевом в пробирку с сусло–агаром контрольную культуру и сохраняли её весь период, по определению не открывая её. Форму описывали и определяли в культурах разного возраста на плотных и жидких средах. Первый просмотр 2–3 сутки культивирования при 25–28 °С, затем культуру оставили при комнатной температуре и описывали. Клетки измеряли микрометром длину и ширину не менее чем у 20 клеток и указывали крайние значения. Измерение производили для культур выращенных на жидких средах. Второй просмотр 1–2 недели при 17–18 °С.
Культуральные свойства полученных колоний Таблица 1
|
№ |
Микроскопическая картина |
Форма колонии |
Профиль колонии |
Край колонии |
Структура колонии |
Цвет колонии |
|
1 |
Кокки- длинные цепочки, дрожжи – единичные клетки. |
Круглая с фестончатым краем, неправильная, амебовидная. |
Изогнутый, кратерообразный, плоский, бугристый, выпуклый, врастающий в агар. |
Струйчатая, зубчатый, волнистый, неправильный, гладкий. |
Мелко- зернистая, однородная. |
Белый. |
|
2 |
Кокки- длинные цепочки, дрожжи – единичные клетки. |
Неправильная, круглая с фестончатым краем, амебовидная. |
Кратерообразный, бугристый, изогнутый, выпуклый. |
Зубчатый, волнистый, струйчатая, гладкий. |
Однородная |
Белый. |
|
3 |
Кокки, палочки, единичные клетки, дрожжи. |
Неправильная |
Плоский изогнутый, выпуклый, врастающий в агар. |
Неправильный, зубчатый, волнистый, струйчатая, гладкий. |
Мелко- зернистая, однородная. |
Белый. |
|
4 |
Кокки, дрожжи. |
Круглая с валиком по краю. |
Бугристый, выпуклый. |
Неправильный, зубчатый, волнистый, струйчатая, гладкий. |
Однородная |
Белый. |
|
5 |
Кокки, дрожжи. |
Круглая с валиком по краю. |
Плоский, выпуклый. |
Волнистый, Зубчатый, волнистый, струйчатая, гладкий. |
Однородная |
Белый. |
|
6 |
Кокки, дрожжи. |
Круглая. |
Бугристый, выпуклый. |
Струйчатая, гладкий. |
Однородная |
Белый. |
|
7 |
Кокки, дрожжи. |
Круглая с валиком по краю. |
Бугристый, выпуклый. |
Зубчатый, гладкий. |
Однородная |
Белый. |
|
8 |
Кокки, дрожжи. |
Круглая с валиком по краю. |
Изогнутый, выпуклый. |
Волнистый, гладкий. |
Мелко- зернистая, однородная. |
Белый. |
|
9 |
Кокки, дрожжи. |
Выпуклый. |
Неправильный, гладкий. |
Однородная |
Белый. |
|
|
10 |
Дрожжи. |
Круглая. |
Плоский, выпуклый. |
Гладкий. |
Однородная |
Белый. |
|
11 |
Дрожжи. |
Круглая . |
Выпуклый. |
Гладкий. |
Однородная |
Белый. |
|
12 |
Дрожжи. |
Круглая. |
Выпуклый. |
Гладкий. |
Однородная |
Белый. |
|
13 |
Дрожжи. |
Круглая . |
Выпуклый . |
Гладкий. |
Однородная |
Белый. |
|
14 |
Дрожжи. |
Круглая. |
Выпуклый. |
Гладкий. |
Однородная |
Белый. |
Вегетативное размножение наблюдали на твёрдых средах в культурах 2–3 суточного возраста.
Культуральные признаки микроорганизмов, при росте на плотных средах описывали по штриху.
Отмечали: цвет, консистенцию, структуру поверхности, форму края или границы роста. Для получения стандартного штриха использовали питательную среду сусло-агар с концентрацией СВ 10%
Рост описывали через 6–8 суток при культивировании при 25 °С, первое описание через 6 недель второе описание.
Рост дрожжей в жидких средах наблюдали при использовании солодового сусла Пивное сусло-агар концентрации СВ 12 % или глюкозо–пептонной среды с дрожжевым экстрактом. Посев производили в пробирки на скошенную питательную среду, и инкубировали 7 дней, при комнатной t (17–18 °C).
В ходе проведённых опытов, приведённых в таблице было выделено 14 штаммов бактерий из которых 5 штаммов дрожжей , и 2 штамма кокков , из которых для дальнейших исследований были использованы штаммы дрожжевых микроорганизмов № 2 которые максимально соответствует нашим требованиям.
Пересевы производили в стерильную плотную питательную среду до получения однородных колоний. После каждого пересева содержимое чашек Петри проверяли на чистоту.
2.4 Определение видовой принадлежности
Чистой культурой считается выращенная масса клеток, состоящая из дрожжей, которые принадлежат одному виду и получены как потомство одной клетки.
Дрожжи в виде чистых культур широко используются в технологии производства многих пищевых продуктов (кисломолочные, сыры, хлеб, вино, пиво и др.). Применение культур дрожжей с известными свойствами дает возможность эффективнее использовать их деятельность — экономичнее перерабатывать сырье, получать высокий выход и надлежащее качество продукции.
Идентификация — определение систематического положения микроорганизмов, выделенных в чистые культуры. Для установления семейства, рода, вида, к которому принадлежат выделенные в чистые культуры дрожжей, необходимо изучить их морфологические, культуральные и физиологические признаки.
Морфологические признаки изучаются под микроскопом в препаратах живых и мертвых микроорганизмов.
Культуральные признаки устанавливаются по характеру роста культуры изучаемого микроорганизма на плотных и жидких питательных средах.
Физиологические признаки, обусловленные наличием ферментов в клетках, устанавливаются при посеве в специальные среды, в состав которых входят те вещества, воздействие на которые выявляется у изучаемого микроба.
Каждый новый штамм микроорганизмов должен быть охарактеризован для получения полных данных о свойствах чистой культуры данного микроорганизма.
Результатом идентификации обычно является отождествление выделенного микроорганизма с каким-нибудь видом или отнесение его к определённому роду.
Полученные данные используют для составления паспорта промышленных штаммов, а так же для их идентификации.
Проведя исследования важнейших морфологических, физиологических и культуральных признаков, устанавливают видовое название микроорганизма по определителю («ключу»). Для каждой группы микроорганизмов (бактерии, дрожжи, грибы) существуют свои определители, составленные с учетом специфических особенностей данной группы.
При описании колоний, выросших на поверхности среды отмечают:
- форму, профиль и цвет- невооружённым глазом;
- край- при малом увеличении микроскопа (объектив 8*);
- консистенцию - прикосновение петли к колонии;
- величину – линейкой ( колонии точечные – менее 1мм в диаметре, мелкие – 1-2 мм, крупные – 3-4 мм и более).
Морфологические свойства изучаемых штаммов микроорганизмов. n=5
Таблица 2.
|
№ штамма |
Морфологические свойства. |
||||
|
Форма |
Размеры, мкм |
Наличие спор |
Почкование |
Подвижность |
|
|
1 |
Клетки круглые и овальные. |
6±0,4 |
+ |
+ |
− |
В результате полученных данных установлено, что размер дрожжевых клеток 6 мкм.
На плотных питательных средах изучают характер колоний. Поскольку колония образуется в результате размножения клеток, её строение зависит от особенностей размножения микробов данного вида и, следовательно, каждому виду присущи характерные признаки.
Культуральные свойства исследуемых штаммов дрожжей n=5
Таблица 3
|
№ колоний |
Культуральные свойства |
||||||
|
Размер |
Профиль |
Форма |
Цвет |
Край |
Консистенция |
структура |
|
|
1 |
Точечный. |
Выпуклый. |
Округлая. |
Белый. |
Гладкий. |
Мягкая. |
Зернистая. |
Физиолого-биохимические свойства изучаемых штаммов
В связи с тем, что 5 исследуемых штаммов по культуральным свойствам были идентичными, для дальнейшего изучения взяли один из них штамм №5. Для определения вида была проведена идентификация по приложению №2.6
Физиолого-биохимические свойства изучаемого штамма Таблица 4
|
Показатели |
№ пробы |
||||
|
1 |
2 |
3 |
4 |
5 |
|
|
Рост на среде Сабуро при температуре 20 оС 36 оС 45 оС |
+ + − |
+ + − |
+ + − |
+ + − |
+ + − |
|
Рост на среде Пивное сусло-агар. 20 оС 36 оС 45 оС |
+ + − |
+ + − |
+ + − |
+ + − |
+ + − |
|
Рост на среде Рисовая –Левиной. 20 оС 36 оС 45 оС |
+ + − |
+ + − |
+ + − |
+ + − |
+ + − |
|
Образование СО>2> из глюкозы |
+ |
+ |
+ |
+ |
+ |
|
Нагревание в течение 30 мин при температуре 60 °С |
− |
− |
− |
− |
− |
|
Сбраживание углеводов: |
+ + + ± + ± |
+ + + ± + ± |
+ + + ± + ± |
+ + + ± + ± |
+ + + ± + ± |
|
Мальтоза Сахароза Лактоза Галактоза Декстрин Раффиноза |
У выделенных штаммов микроорганизмов, рост наблюдается при температуре от 19 − 36 ºС. Оптимальной для культивирования штамма является температура от 30 − 35°С. При культивировании на рисовой среде Левиной, испытуемого штамма дрожжей наблюдается спорообразование. Образование СО>2 >из глюкозы наблюдается в аэробных условиях. Выделенный штамм сбраживает следующие углеводы: мальтоза, сахароза, лактоза, декстрин; галактоза, раффиноза − частично.
Культуральные свойства Saccharomyces
Клетки круглые и овальные, иногда удлиненные. Вегетативное размножение многосторонним почкованием. Может быть примитивный псевдомицелий, истинного мицелия нет. Колонии обычно пастообразные. На жидких средах при продолжительном культивировании может образовываться пленка, но она не бывает сухой порошковидной или всползающей. Аски образуются преимущественно из вегетативных диплоидных клеток без непосредственно предшествующей конъюгации. При созревании спор сумки не вскрываются. Аскоспоры круглые или слабоовальные, бесцветные, гладкие, 1 — 4 в аске. Все виды активно сбраживают сахара и не используют нитраты. Лактозу и высшие парафины не ассимилируют. Дрожжи этого рода с давних времен распространены в кустарном виноделии и широко используются в разных отраслях бродильной промышленности, в связи с чем они более всех других дрожжей изучены в разных аспектах. Их систематика, однако, постоянно пересматривается. Центральный вид — Saccharomyces cerevisiae Hansen известен в десятках синонимов, которые в настоящее время рассматриваются как производственные расы, но не самостоятельные виды.
В разных определителях объем рода Saccharomyces сильно варьирует. Ван дер Вальт в определителе Лоддер [55] различает 41 вид, среди которых есть диплоидные, гаплоидные и виды с соматогамной автогамией. В. И. Кудрявцев [11] включает в род Saccharomyces только диплоидные дрожжи, выделяя гаплоидные виды в Zygosaccharomyces, а виды с автогамным половым процессом — в род Debaryomyces. В результате полученных данных, при изучении физиологических свойств штамма, установлено, что данный штамм относится к дрожжам и предварительно идентифицирован как Saccharomyces сеrеvisiае. (рис.3.в приложении № 2.)
Основные показатели процесса культивирования дрожжей
Для определения химического состава дрожжей, нам было необходимо накопить определенное количество биомассы. С этой целью мы использовали ферментер БИОЛУК-3Ш, аппарат для непрерывного культивирования микроорганизмов. Установка может использоваться при процессах переработки субстратов сложного химического состава, для интенсификации микробиологических процессов, а также для ускоренного автоматического отбора активных штаммов, перспективных при использовании в различных областях народного хозяйства и промышленности. Установка-БИОЛУК-3Ш может использоваться при исследованиях в генетике, биохимии, микробиологии, физиологии и экологии.
Технологические характеристики установки БИОЛУК-3Ш
Установка может работать с ферментерами объемом 0,1-10 л
Объем культуры в ферментерах 0,05-7 л
Скорость вращения мешалки до 1500 об/мин
Аэрация 0-2,76 л/мин
Производительность дозатора 20-400 мл/час
Автоматическая стабилизация рН от 2 до 12
Потребляемая мощность 600 Вт
Напряжение питания 220 В, 50 Гц
Вес 25 кг
Принцип действия установки БИОЛУК-3Ш
Установка работает следующим образом. Питательная среда при помощи перистальтического насоса дозатора по силиконовому шлангу подается в ферментер. Скорость подачи среды в ферментер регулируется в зависимости от цели и задачи исследования, то есть в режиме рН-стата, хемостата. Воздух ферментер поступает от микрокомпрессора через ротаметр, показывающий расход воздуха, воздушный и водяной фильтр, служащий для стерилизации и увлажнения подаваемого воздуха для насыщения кислородом культуральной жидкости. Перемешивание культуральной жидкости осуществляется вращением мешалки на основе электродвигателя. Регистрация и управление параметров растущей культуры происходит с помощью датчиков рН, еН, рО2 и др. Выбор датчиков определяется задачей исследования для стабилизации температуры в ферментере предусмотрено устройство, соединенное с термостатом, для поддержания заданной температуры. Излишки культуральной жидкости из ферментера уносятся воздухом через сливную трубку в бак для урожая.
Подъемная сила и бродильная энергия таких дрожжей понижается, в процессе выращивания наблюдается отмирание части дрожжевых клеток. Количество мертвых клеток составляет около 7 %. В связи с этим на протяжении всего процесса культивирования нами поддерживалось температура 28 – 300 С.
Основные показатели процесса культивирования дрожжей. Таблица 5
|
Часы культивирования |
t0С среды |
Биомасса г/л |
||
|
Номер опыта |
||||
|
1 |
2 |
3 |
||
|
Начальная |
28-30 |
1,82 |
1,71 |
1,93 |
|
1 |
28-30 |
3,63 |
3,34 |
4,05 |
|
2 |
28-30 |
16,69 |
18,76 |
19,75 |
|
3 |
28-30 |
37,04 |
37,14 |
37,12 |
|
4 |
28-30 |
49,38 |
49,52 |
49,49 |
|
5 |
28-30 |
61,73 |
61,90 |
61,86 |
|
6 |
28-30 |
74,08 |
74,28 |
74,24 |
|
7 |
28-30 |
88,78 |
89,04 |
88,98 |
Во время культивирования дрожжей нами каждый час определялись следующие показатели: температура, прирост биомассы и количество дрожжевых клеток в мл.
Дрожжевые клетки, как и все микроорганизмы, при культивировании развиваются по четырем фазам роста: лагфаза, фаза логарифмического роста, стационарная фаза и фаза отмирания. Однако наша работа предусматривает только первые три фазы.
Лагфаза – это период, во время которого внесенные в питательную среду дрожжевые клетки адаптируются к окружающей среде.
Фаза логарифмического роста характеризуется высокой активностью размножения клеток. Количество почкующихся клеток быстро увеличивается, достигая 70 – 80%. Биомасса дрожжей увеличивается вследствие образования новых дочерних клеток, которые, вырастая до размеров материнской клетки, начинают почковаться, образуя новую генерацию. После отпочковывания молодой клетки материнские клетки вновь начинают почковаться, т.е. в этой фазе наблюдается максимальная скорость роста дрожжевых микроорганизмов.
В стационарной фазе образование новых клеток практически прекращается, заканчивается также и почкование, так как питательные вещества в дрожжерастительный аппарат не поступают. Для поддержания жизнедеятельности клетки используют оставшиеся питательные вещества. Увеличивается масса и размер клеток. Эта фаза соответствует их дозреванию.
Фаза отмирания характеризуется отсутствием роста и размножения микроорганизмов. Масса клеток уменьшается, наблюдается автолиз. Качество клеток резко ухудшается.
Содержание питательных веществ в биомассе дрожжей, n=5
В полученных нами дрожжах были определены следующие показатели:
сухое вещество – высушиванием в сушильном шкафу при температуре 60°С;
гигроскопическая влажность – высушиванием в сушильном шкафу при температуре 100 – 105° С, ГОСТ 1396.3 – 92 (27548 - 97);
«сырой» жир – в аппарате Сокслета, ГОСТ 13496.65;
«сырой» протеин – по методу Къельдаля, ГОСТ 1396.4 (28074 – 89);
«сырая» зола – методом сухого озоления (температура 400 – 4500С), ГОСТ 26226 – 95;
БЭВ – расчетным методом.
В полученных нами дрожжах были определены показатели, которые представлены в таблице 6.
Химический состав дрожжей Таблица 6
-
Показатель
Содержание в дрожжах
Сухое вещество, %
28,1±1,2
Влага, %
71,9±3,5
«Сырой» протеин, %
41,4±1,5
«Сырой» жир, %
1,8±0,7
«Сырая» зола, %
8,8±1,2
БЭВ, %
48±3,1
Содержание сухого вещества составило 28,1 %, влаги около 80%, протеина 41,4%, жира 1,8%, золы 8,8%. Содержание БЭВ (Безазотистых Экстрактивных Веществ) составило 48%.
Из анализа выше приведенных данных следует, что исследуемые штаммы дрожжей можно отнести к роду Saccharomyces виду сеrеvisiае.
2.5 Обсуждение результатов
1. Вегетативное размножение наблюдали на твёрдых средах в культурах 2–3 суточного возраста, культуральные признаки, описывали по штриху. Отметили: круглую форму колоний, выпуклый профиль, гладкие края и однородную структуру. Цвет колоний – белый.
2. В ходе проведённых опытов, было выделено 5 штаммов дрожжей, из которых для дальнейших исследований были использованы штаммы дрожжевых микроорганизмов, которые максимально соответствует нашим требованиям, по фенотипическим признакам.
3. Пересевы производили в стерильную плотную питательную среду до получения однородных колоний. После каждого пересева содержимое чашек Петри проверяли на чистоту культуры.
4. На плотных питательных средах изучают характер колоний. Поскольку колония образуется в результате размножения клеток, её строение зависит от особенностей размножения микробов данного вида и, следовательно, каждому виду присущи характерные признаки. В результате размеры клеток 6 ± 0,4мкм, отметили также наличие спорообразования и почкования. Клетки не подвижны.
5. У выделенных штаммов микроорганизмов, рост наблюдается при температуре от 19 − 36 ºС. Оптимальной для культивирования штамма является температура от 30 − 35°С. В процессе культивирования была получена биомасса дрожжей (88,98 г/л.)
7. Выделенный штамм сбраживает углеводы. Наблюдается спорообразование, при культивировании на рисовой среде Левиной. Образование СО>2 >из глюкозы − в аэробных и анаэробных условиях.
6.Содержание сухого вещества составило 28,1 %, влаги около 80%, протеина 41,4%, жира 1,8%, золы 8,8%. Содержание БЭВ (Безазотистых Экстрактивных Веществ) составило 48%. В результате полученных данных, установлено, что данный штамм относится к дрожжам и предварительно идентифицирован как Saccharomyces сеrеvisiае.
Глава 3 Экономическая эффективность
Одно из важнейших направлений повышения эффективности производства в пищевой промышленности – снижение материалоемкости. Пивоваренная промышленность относится к числу наиболее материалоемких отраслей. Удельный вес материальных затрат в издержках производства в пивоваренной промышленности достигает 80%. Эффективное использование материальных ресурсов в пивоварении означает снижение себестоимости продукции и более эффективное использование сельскохозяйственного сырья.
Материалоемкость производства определяется величиной материальных затрат, приходящихся на 1 руб. товарной продукции.
Основным элементом материальных затрат являются затраты на зерновое сырье. На величину затрат зернового сырья в стоимостном выражении существенное влияние оказывают закупочные цены на ячмень, удельный вес товарного солода, состав закупаемого зерна по классам.
В экономическом смысле себестоимость — это денежное выражение затрат предприятия на производство и реализацию продукции. Количественно она не совпадает с той частью стоимости, которую отражает, поскольку потребленные в процессе производства орудия (машины, оборудование и т. д.) и предметы труда (питательные среды), включаются в себестоимость продукции не по общественно необходимым затратам, а по действующим ценам которые, как правило, не совпадают со стоимостью.
Основу себестоимости продукции, (работ, услуг) составляют затраты прошлого и живого труда. Прошлый труд заключен в средствах производства, которые оцениваются по фактическим ценам приобретения, а материалы собственного производства (агар, пептон и т. д.) — по себестоимости. Живой труд учитывается в размере его фактической оплаты, включая и часть затрат по воспроизводству рабочей силы.
Себестоимость продукции (работ, услуг) представляет собой стоимостную оценку используемых в процессе их производства природных ресурсов, сырья, материалов, топлива, энергии, основных фондов, трудовых ресурсов, а также других затрат на ее производство и реализацию. Таким образом, она отражает величину таких затрат, которые обеспечивают процесс простого воспроизводства на предприятии; это форма возмещения потребляемых факторов производства.
Основным направлением повышения эффективности производства в пищевой промышленности является более полное использование производственных мощностей и основных фондов предприятия, а также рост производительности труда и улучшения качества продукции. (Опарин Н.Г., 2003).
Валовая продукция - это стоимость всей произведенной, продукции и выполненных работ, включая незавершенное производство. Выражается в сопоставимых и действующих ценах.
Товарная продукция отличается от валовой тем, что в нее не включают остатки незавершенного производства и внутрихозяйственный оборот. По своему составу на многих предприятиях валовая продукция совпадает с товарной, если нет внутрихозяйственного оборота и незавершенного производства.
Расчет себестоимости и производства.
Сырье и основные материалы. Стоимость сырья и основных материалов для производства продукции представлена в таблице.
Таблица 7 Стоимость сырья и основных материалов, используемых при производстве 100г. дрожжей
|
Наименование затрат |
Норма расхода, г. |
Цена руб., кг. |
Сумма, руб. |
|
Хмель |
200 |
50 |
10 |
|
Дрожжи ( для приготовления автолизата) |
240 |
400 |
60 |
|
Агар |
80 |
961,08 |
160 |
|
Пептон |
20 |
908,76 |
30 |
|
Витамин В>1> |
100 |
400 |
40 |
|
Витамин В>12> |
100 |
320 |
32 |
|
Глюкоза |
100 |
1080 |
108 |
|
Сахароза |
30 |
1200 |
120 |
|
Галактоза |
25 |
1000 |
25 |
|
Раффиноза |
15 |
960 |
14,4 |
|
Лактоза |
15 |
1100 |
16,5 |
|
Фильтры бумажные |
50шт. |
600 |
600 |
|
Вода |
− |
− |
− |
|
Итого: |
1215,9 |
Остальные составляющие затрат сводятся в следующих таблицах.
1. Вспомогательные материалы.
С учетом промышленных выработок установлены затраты по статье по данной статье в размере 1,1% стоимости затрат по статье «Сырье и основные материалы».
(1215,9 : 100) * 1,1= 13,374 руб.
2. Транспортно-заготовительные расходы
На основании анализа затрат при производстве дрожжей установлены затраты по статье в размере 2% стоимости затрат на закупку сырья и материалов.
1215,9* 0,02=24,318 руб.
Таблица 8 Стоимость топлива и энергии, используемые при производстве продукта
|
Наименование затрат |
Чистая культура м/о. |
||
|
Норма расхода |
Цена, руб |
Сумма, руб |
|
|
Электроэнергия, кВ/ч |
25 |
2,2 |
55 |
|
Вода и канализация, куб. м |
2,4 |
26,5 |
63,6 |
|
Итого |
118,6 |
4 Глава Экологическая безопасность
Экология является теоретической основой рационального природоиспользования, ей принадлежит ведущая роль в разработке стратегии взаимоотношений природы и человеческого общества. Промышленная экология рассматривает нарушение природного равновесия в результате хозяйственной деятельности. При этом наиболее значительным по своим последствиям является загрязнение окружающей среды. Под термином «окружающая среда» принято понимать все то, что прямо или косвенно воздействует на жизнь и деятельность человека.
По-новому следует оценивать и роль дрожжей в природных экосистемах. Например, считавшиеся долго безвредными комменсалами многие эпифитные дрожжи, обильно обсеменяющие зеленые части растений, могут оказаться не такими уж «невинными», если учесть, что они представляют собой лишь гаплоидную стадию в жизненном цикле организмов, близко родственных фитопатогенным головневым или ржавчинным грибам. И, наоборот, патогенные для человека дрожжи, вызывающие опасные и трудноизлечимые болезни - кандидоз и криптококкоз - в природе имеют сапротрофную стадию и легко выделяются из мертвых органических субстратов. Из этих примеров видно, что для понимания экологических функций дрожжей необходимо изучение полных жизненных циклов каждого вида. Обнаружены и автохтонные почвенные дрожжи с особыми функциями, важными для образования почвенной структуры. Неисчерпаемы по многообразию и связи дрожжей с животными, особенно с беспозвоночными.
Загрязнение атмосферы может быть связано с естественными процессами: извержением вулканов, пыльными бурями, лесными пожарами.
Кроме того, атмосфера загрязняется в результате производственной деятельности человека.
Источниками загрязнения воздуха является дымовые выбросы промышленных предприятий. Выбросы бывают организованными и неорганизованными. Выбросы, поступающие из труб промышленных предприятий, является специально направленными, организованными. До того как поступить в трубу, они проходят через очистные сооружения, в которых осуществляется поглощение части вредных веществ. Из окон, дверей, вентиляционных отверстий производственных зданий в атмосферу поступают неорганизованные выбросы. Основными загрязняющими веществами в выбросах являются твердые частицы (пыль, сажа) и газообразные вещества (окись углерода, двуокись серы, окислы азота).
Селекция и идентификация микроорганизмов с полезными для определенного производства свойствами является весьма актуальной с экологической точки работой, так как их использование может интенсифицировать процесс или более полно использовать компоненты субстрата.
Сущность методов биоремедиации, биологической очистки, биопереработки и биомодификации заключается в использовании в окружающей среде различных биологических агентов, в первую очередь микроорганизмов. При этом можно применять как микроорганизмы, полученные традиционными методами селекции, так и созданные с помощью генной инженерии, а также трансгенные растения, которые могут влиять на биологическое равновесие природных экосистем.
В окружающей среде могут присутствовать промышленные штаммы различных микроорганизмов - продуцентов биосинтеза тех или иных веществ, а также продукты их метаболизма, которые выступают как биологический фактор загрязнения. Действие его может заключаться в изменении структуры биоценозов. Косвенные эффекты биологического загрязнения проявляются, например, при использовании антибиотиков и других лекарственных средств в медицине, когда появляются штаммы микроорганизмов, устойчивые к их действию и опасные для внутренней среды человека; в виде осложнений при использовании вакцин и сывороток, содержащих примеси веществ биологического происхождения; как аллергенное и генетическое действие микроорганизмов и продуктов их метаболизма.
Биотехнологические крупнотоннажные производства являются источником эмиссии биоаэрозолей, содержащих клетки непатогенных микроорганизмов, а также продукты их метаболизма. Основные источники биоаэрозолей, содержащих живые клетки микроорганизмов, - стадии ферментации и сепарации, а инактивированных клеток - стадия сушки. При массированном выбросе микробная биомасса, попадая в почву или в водоем, изменяет распределение потоков энергии и вещества в трофических цепях питания и влияет на структуру и функцию биоценозов, снижает активность самоочищения и, следовательно, влияет на глобальную функцию биоты. При этом возможно провоцирование активного развития определенных организмов, в том числе микроорганизмов санитарно-показательных групп.
Динамика интродуцированных популяций и показатели их биотехнологического потенциала зависят от вида микроорганизма, состояния почвенной микробной системы в момент интродукции, этапа микробной сукцессии, дозы внесенной популяции. При этом последствия внедрения микроорганизмов, новых для почвенных биоценозов, могут быть неоднозначными. Вследствие самоочищения элиминируется не всякая интродуцированная в почву микробная популяция. Характер популяционной динамики интродуцируемых микроорганизмов зависит от степени их приспособленности к новым условиям. Неприспособленные популяции погибают, приспособленные сохраняются.
Биологический фактор загрязнения можно определить как совокупность биологических компонентов, воздействие которых на человека и окружающую среду связано с их способностью размножаться в естественных или искусственных условиях, продуцировать биологически активные вещества, а при их попадании или продуктов их жизнедеятельности в окружающую среду оказывать неблагоприятные воздействия на окружающую среду, людей, животных, растения.
Биологические факторы загрязнения (чаще всего микробные) можно классифицировать следующим образом: живые микроорганизмы с природным геномом, не обладающие токсичностью, сапрофиты, живые микроорганизмы с природным геномом, обладающие инфекционной активностью, патогенные и условно-патогенные, вырабатывающие токсины, живые микроорганизмы, получаемые методами генной инженерии (генетически модифицированные микроорганизмы, содержащие чужие гены или новые комбинации генов - ГММО), инфекционные и другие вирусы, токсины биологического происхождения, инактивированные клетки микроорганизмов (вакцины, пыль термически инактивированной биомассы микроорганизмов кормового и пищевого назначения), продукты метаболизма микроорганизмов, органеллы и органические соединения клетки - продукты ее фракционирования.
Целью нашей работы явилось выделение и идентификация дрожжевых микроорганизмов в лаборатории биотехнологии Горского ГАУ, относящихся к первой группе выше перечисленных организмов. Так как это микроорганизмы с природным геномом и не обладающие токсичностью, то их воздействие на окружающую среду весьма органично и не значительно.
Источниками микроорганизмов, включая условно-патогенные и патогенные, являются сточные воды (хозяйственно-фекальные, производственные, городские ливневые стоки). В сельских районах фекальные загрязнения поступают со стоками населенных мест, с пастбищ, загонов для скота и птиц и от диких животных. В процессе обработки сточных вод количество патогенных микроорганизмов в них снижается. Масштабы их действия на окружающую среду незначительны, тем не менее поскольку этот источник эмиссии микробных клеток существует, его необходимо учитывать как фактор загрязнения окружающей среды.
Вода, используемая в процессе выполнения нашей работы для приготовления сред, смывов, обогрева автоклава и термостатов может быть очищена на городских очистных сооружениях вместе с городскими сточными водами аэробным или анаэробным способом.
Биологические загрязнители по экологическим свойствам существенно отличаются от химических. По химическому составу техногенные биологические загрязнения тождественны природным компонентам, они включаются в природный круговорот веществ и трофические цепи питания без аккумулирования в окружающей среде.
Все микробиологические и вирусологические лаборатории должны быть оснащены приемником сточных вод, где собирающиеся стоки перед сбросом в городскую канализацию обязательно обезвреживаются химическим, физическим или биологическим методом либо комбинированным способом.
Глава 5 Безопасность жизнедеятельности
Двойная цель техники лабораторной безопасности заключается в защите, как эксперимента, так и экспериментатора, но безопасность человека стоит, конечно, на первом месте.
Из того факта, что обычно используемые бактерии присутствуют в окружающей среде, как будто следует, что они безвредны для человека. Действительно, между непатогенностью и патогенностью нет резкой границы; фактически бактерии имеют широкий спектр степени вирулентности по отношению к человеку. Вчерашний сапрофит сегодня может стать паразитом, а завтра возбудителем заболевания (в качестве примеров можно назвать Escherichia coli, Proteus vulgaris, Pseudomonas aeruginosa, Serratia marcescens и Bacillus cereus). Никогда нельзя забывать, что со всеми бактериями следует работать как с потенциальным источником опасности для здоровья человека.
Мероприятия по предотвращению заражения людей и контаминации окружающего оборудования.
При работе необходимо тщательно выполнять следующие меры предосторожности.
1. Держать двери лаборатории закрытыми.
2. Перед мытьем или повторным употреблением, оборудование, используемое в боксовой работе, должны быть автоклавированы или дезинфицированы.
3. Использовать устройства для набирания жидкости в пипетки.
4. Не есть, не пить и не курить в лаборатории.
5. Мыть руки после работы в лаборатории.
6. Все процедуры и манипуляции выполнять осторожно, сводя к минимуму образование аэрозолей.
7. На соответствующих лабораторных дверях установить знаки биологической опасности. Морозильники, холодильники и другие места хранения патогенных бактерий также должны быть снабжены этим знаком.
8. Надевать защитную одежду или халаты. Не носить эту одежду вне лаборатории.
9. Иметь аптечку экстренной профилактики.
После окончания боксовой работы помещение убирают и облучают бактерицидными лампами в течение 30 − 60 мин. Помещение боксов моют не менее раза в неделю горячей водой с мылом, дезинфицирующими средствами.
Работа с пипетками
Следует использовать безопасные способы применения пипеток. Насасывание раствора пипеткой было причиной бактериального заражения в лабораторных условиях более чем в 17% всех известных случаев.
Дополнительная опасность действия аэрозолей возникает, когда жидкость из пипетки капают на рабочую поверхность, перемешивают культуру чередованием всасывания и выдувания, интенсивно выдувают культуру в чашку или выдувают последнюю каплю из пипетки.
Чтобы использование пипеток было безопасным, применяют дополнительные приспособления, предотвращающие опасность заглатывания, и стараются обращаться с ними осторожно. Существует множество приспособлений к пипеткам− от простых шаровидных груш и поршневых насасывателей до сложных конструкций, имеющих свои собственные насосы, создающие вакуум. При выборе приспособления надо иметь в виду тип операции, которую требуется выполнить, легкость выполнения, а также ее точность.
Предварительно следует отработать технику использования пипеток, чтобы уменьшить возможность образования аэрозолей.
В верхнюю часть пипетки вставляют кусочки ваты и стараются избегать быстрого смешивания жидкостей путем чередования всасывания и выдувания их из пипеток. Нельзя с силой выдувать раствор из пипетки и допускать попадания пузырьков воздуха в жидкость, набираемую пипеткой. Предпочтительнее использовать пипетки, при работе с которыми не требуется выдувания последней капли.
Необходимо также следить за тем, чтобы культуральный материал не капал из пипетки. Можно при работе с суспензиями, содержащими патогенные бактерии, на рабочую поверхность класть полотенце, пропитанное дезинфицирующим веществом. Жидкость из пипеток выливают таким образом, чтобы кончик пипетки находился почти над уровнем жидкости или агара в сосуде − приемнике или раствор стекал по его стенке. Грязные пипетки помещают в емкости с дезинфицирующим раствором, полностью погружая в него.
Правила работы с лабораторным оборудованием.
Центрифугирование
Все лабораторное оборудование должно иметь защиту от статического электричества тока (заземление).
При центрифугировании суспензий следует пользоваться безопасными центрифужными гильзами. Перед центрифугированием проверяют стаканы, и если находят трещины или сколотые края, то такими стаканами не пользуются. Внимательно осматривают внутреннюю поверхность гильз и ликвидируют шероховатости или приставшие частицы. Проверяют также состояние резиновых прокладок.
Не рекомендуется закрывать центрифужные стаканы алюминиевой фольгой, потому что при центрифугировании она часто слетает или рвется.
Стаканы и гильзы необходимо тщательно уравновешивать. Не следует смешивать гильзы, стаканы и пластмассовые вкладыши из разных наборов. Если на этих предметах не указан вес, удобно пометить каждый комплект своей краской.
После включения центрифуги заданную скорость вращения достигают не сразу, а постепенно увеличивая число оборотов ротора. Крышку центрифуги открывают не ранее, чем после полной остановки ротора.
Металл, из которого сделаны высокоскоростные роторы, постепенно изнашивается, и если их используют на разных центрифугах, то для каждого заводят тетрадь, в которой отмечают количество часов работы на предельной или пониженной скорости. Если это не соблюдается, может произойти опасная и дорогостоящая поломка. Чтобы предотвратить коррозию или другие дефекты, которые могут привести к развитию трещин, необходимы частые проверки роторов, их очистка и сушка. Регулярно проверяют состояние резиновых колец и крышек центрифужных стаканов и смазывают их в соответствии с рекомендациями фирмы − изготовителя.
Инструменты
Инструменты, термометры, пипетки и стеклянная посуда перед новым использованием должны быть обеззаражены. В тех случаях, когда перед употреблением необходимо обеззараживание, для дезинфекции используют раствор 2%-ного глутарового альдегида. Предметы полностью погружают в раствор на 20-30 мин. При этом полная безопасность не гарантируется, если предмет не был предварительно вымыт или если раствор уже использовали ранее. Перед повторным употреблением инструменты необходимо тщательно прополоскать в дистиллированной воде. Лабораторные пипетки обеззараживают погружением в дезинфицирующий раствор, налитый в вертикальную или горизонтальную емкость. Стеклянную посуду погружают полностью. Перед использованием стеклянную посуду стерилизуют паром.
Личная гигиена
Еду, конфеты, жевательную резинку и напитки нельзя хранить и употреблять в лабораторных комнатах. Курение в рабочих помещениях запрещено.
Нежелательно, чтобы работающие в лаборатории имели бороду, во-первых, потому что в бороде могут сохраняться частички с бактериями и, во-вторых, потому, что маска или респиратор к чисто выбритому лицу прилегает гораздо лучше, чем к лицу с бородой.
Руки не следует подносить близко ко рту, носу, глазам, лицу и волосам, чтобы предотвратить самозаражение.
Личные вещи, такие, как пальто, шляпы, плащи, уличную обувь, зонты и кошельки, необходимо хранить вне лабораторных помещений.
После снятия защитных перчаток следует немедленно вымыть руки. Проверочные опыты показывают, что, даже когда используют перчатки, не исключено попадание на руки бактерий. Бактерии могут проникнуть через незаметные маленькие дырочки, трещины или разрывы или попасть через край перчатки, прилегающий к запястью.
Руки нужно мыть, сняв запачканную защитную одежду, перед выходом из лаборатории, перед едой иди курением и в течение дня через интервалы, определяемые, характером работы. Желательно мыть руки в дезинфицирующем растворе или погружать их в него, но при этом, конечно, не следует допускать огрубения, чрезмерного высушивания или раздражения кожи.
К работе с бактериями нельзя допускать людей со свежим или старым порезом, ссадиной, повреждением кожи или любой открытой раной, включая образовавшуюся после удаления зуба.
Руки
Для обычного мытья рук в лаборатории, когда не имеют дела с инфекционными агентами, можно применять разные моющие средства. Тщательное мытье рук в течение 15-20 с дезинфектантом приводит к сокращению числа бактерий более чем на 50%.
Мыло в кусках использовать не рекомендуется не только из-за грязи в мыльнице, но также потому, что некоторые микроорганизмы сохраняют жизнеспособность на мыле в течение некоторого времени. Если в резервуар с жидким мылом не добавлять предохраняющих средств, то там могут постепенно вырасти многочисленные популяции бактерий. В этом случае резервуар следует вымыть обычным способом и налить туда новое мыло. Порошковые и листовые мыла имеют то преимущество, что они не загрязняются бактериями, и бактерии не способны расти на них.
СПИСОК ИСПОЛЬЗОВАННОЙ ЛИТЕРАТУРЫ
Александров А.Н., Влияние качества стеблевых черенков на рост, развитие и урожай хмеля. – Чебоксары: Труды РНИХС. Чувашкнигоиздат 1975. – Вып.5. – С. 84–88.
Альшевский Н.Г., Вержбицкий В.И. Действие кальция, магния и бора на урожай и качество шишек хмеля. Хмелеводство. – К.; Урожай, 1975. – Вып. 5. – 58–60 с.
Альшевский Н.Г., Вержбицкий В.И. Химический состав растений хмеля и использование ими элементов минерального питания при удобрении кальцием, магнием и бором. Хмелеводство. – К.; Урожай, 1979. – Вып. 1. –35–39 с.
Главачек Ф., Лхотский А. Пивоварение. – М.; Пищевая промышленность 1977. –625с.
Шуляр В.М., Рейтман И.Г., Зинчинко С.А. Изменение пивоваренных качеств украинских сортов хмеля в процессе хранения. Биологические основы повышения урожайности сельскохозяйственных культур: Научные труды УСХА. – К.; 1980. – Вып. 245. –128–130 с.
Соловьёва О.И. Теоретические основы товароведения и экспертизы потребительских товаров: Учебное пособие. – Омск: Изд-во ИВМ ОмГАУ, 2003. 304 с
Виноградов В.Н., Сергеев Л. За высокие урожаи хмеля. Земля родная. – М.: 1977. − Вып.1. − 34–36 с
Биотехнология принципы и применение. Под редакцией Хиггинс И., Бест Д., Джонс Д.-М.: Мир, 1988, С. 116.
Остроменьский А.Б. Влияние дополнительной упаковки шишек хмеля в полиэтиленовую пленку на их качество в процессе хранения. Хмелеводство. К.; Урожай, 1979. – Вып.1. –67–70 с.
Щербатенко В. В. Регулирование технологических процессов производства хлеба и повышение его качества. — М.: Пищевая промышленность, 1976. — 232 с Довгань В.Н. Книга о пиве.– Смоленск: Русич, 1996.– 576с
Рейтман И.Г. Вопросы теории сушки хмеля. Хмелеводство. – К.; Урожай, 1975. – Вып. 4. –79– 96 с.
Либацкий Е.П Хмелеводство. М. Колос 1993. –279 с.
Бондаренко В.М. К вопросу содержания горьких веществ в шишках хмеля. Тр. УНИСХ. – 1959. –Вып. 6. –101–109 с.
Вержбицкий В.И., Полищук В.Д. Образование отдельных компонентов горьких веществ в органах хмеля. Хмелеводство. – К.; Урожай, 1975. − Вып.1. −40- 45 с.
Альшевский Н.Г., Москальчук Н.И. Магний в питании хмеля. Хмелеводство. 1982. – Вып.4. –23–27 с.
Аркадьева З.А., Безбородов А.М., Блохина И.Н. и др. Промышленная микробиология. Под ред. Н. С. Егорова. – М. Высш. шк., 1989. –688 с.
Бабицкая В.Г., Стахеев И.В. Микробиологическая промышленность.- М.: ОНИТЭИ Микробиопром, 1977, № 11, –32 С.
Бабьева И.П., Голубев В. И. Методы выделения и идентификации дрожжей.м.: Пищевая пром-сть, 1979. – 120 с.
Барабай В.А. Биологическое действие растительных фенольных соединений. – К.; Наук. думка, 1976. – 270 с.
Крылова М.И., Батудаева Э.А. Выращивание саженцев хмеля из зеленых черенков. Научные труды РНИХС, вып.6. М.: 1982.
Биотехнология принципы и применение. Под редакцией Хиггинс И., Бест Д., Джонс Д.М.: Мир, 1988, С. 116.
Коновалов С.А. Биохимия бродильных производств.- М.; Пищевая промышленность, 1967.
Коновалов С.А. Биохимия дрожжей. – М.: Пищевая промышленность, 1962. –269 с.
Андреев А.А., Брызгалов Л.И. Производство кормовых дрожжей. 3- е изд. перераб. и доп. – М.: Лесная пром-сть, 1986.– 248 с.
Безбородов А.М. Биотехнологические основы микробиологического синтеза.– М.: Лег. и пищ. пр-сть, 1984, 204 с.
Воробьева Л.И. Техническая микробиология. Учеб. пособие. – М.:Изд-во МГУ,1987.– 168 с.
Воробьева Л.И.Промышленная микробиология. Учеб. пособие.- М.: Изд-во МГУ, 1989 – 294 с.
Жвирблянская А.Ю., Исаева В.С. Дрожжи в пивоварении. М.; Пищевая промышленность, 1979. –246 с.
Справочник по виноделию (Под ред. Г.Г. Валуйко и В.Т. Косюры). – Симферополь: Таврида, 2000. – 624 с.
Теория и практика виноделия Ж.Риберо-Гайон, Э.Пейно, П.Риберо-Гайон, П.Сюдро. – М. Пищевая промышленность, 1979. – Т.2. – 352 с; 1980, т. 3. – 480 с., 1981, т. 4 – 414 с.
Фертман Г.И., Шойхет М.И, Химико-технологический контроль спиртового и ликеро-водочного производства. – М.:Пищевая промышленность, 1975. – 440 с.
Фараджева Е.Д., Болотов Н.А. «Производство хлебопекарных дрожжей» Санкт-Петербург 2002
Семихатова Н. М., Малыгина М. В. Микробиология дрожжевого производства. М., «Пищевая промышленность», 1970.
Розманова Н.В., Бочарова Н.Н. Новые методы микробиологического контроля дрожжевого производства. — В кн.: Новое в микробиологии и технологии дрожжевого производства. М., ЦИНТИ пищепром, 1967.
Малков А. М. Технология хлебопекарных и кормовых дрожжей. М.,Пищепромиздат, 1962.
Грачёва. И.М. Технология микробных белковых препаратов, аминокислот и биоэнергия И.М. Грачёва, Л.А. Иванова. В.М. Кантере – 2– е изд., перераб. и доп. – М: Колос,1992. –383 с.
Гриневич. А.Г., Босенко. А.М. Техническая микробиология. Учеб. пособ. для технол. вузов – Мн.: Высш. шк. 1986.–168 с.
Инструкция по микробиологическому и технохимическому контролю дрожжевого производства. М. “Легкая и пищевая промышленность”, 1978, 165 с.
Новаковская С. С.. Справочник технолога дрожжевого производства. М. “Пищевая промышленность” 1973, 269с.
Пименова М. К, Гречушкина Н. Н.,Азов а Л. Г. Руководство к практическим занятиям по микробиологии. Изд-во МГУ, 1971.
Работнова И. Л. Общая микробиология. М., «Высшая школа», 1966.
Романе I к о В. И., Кузнецов С. И. Экология микроорганизмов пресных, водоемов. Лабораторное руководство. Л., «Наука», 1974.
Роуз Э. Химическая микробиология. М., «Мир», 1971.
Ляшенко Н.И. Биохимическая характеристика некоторых сортов хмеля. Прикладная биохимия и микробиология. – 1977. – № 1. С.118 –123.
Ляшенко Н.И. Изменение горьких веществ в цветках и шишках хмеля. Физиология и биохимия культурных растений. – К.; Наук. думка. 1976. –Т.8, вып. 3. –307–312 с.
Шлегель Г. Общая микробиология. М., «Мир», 1972.
Для выполнения работы были использованы следующие Интернет сайты:
http://soil.msu.ru/soilyeasts/pics/Invertebrate.htm
http://soil.msu.ru/soilyeasts/pics/SoilAutochthons.htm
http://soil.msu.ru/soilyeasts/pics/Colonies.htm
http://soil.msu.ru/soilyeasts/pics/LiquidMedia.htm
http://soil.msu.ru/soilyeasts/pics/AscosporeForms.htm
http://soil.msu.ru/soilyeasts/pics/Ingibitors.htm
http://soil.msu.ru/soilyeasts/pics/Pasteur.htm
http://soil.msu.ru/soilyeasts/pics/Kluyver.htm
http://soil.msu.ru/soilyeasts/pics/Nadson.htm
http://soil.msu.ru/soilyeasts/pics/Candidose.htm
http://soil.msu.ru/soilyeasts/pics/Criptococcose.htm
http://soil.msu.ru/soilyeasts/pics/LifeCycle.htm
http://soil.msu.ru/soilyeasts/pics/Epiphtes.htm
http://soil.msu.ru/soilyeasts/pics/Commensals.htm
http://soil.msu.ru/soilyeasts/pics/Uredinales.htm
http://soil.msu.ru/soilyeasts/genera/Tremellales.htm
http://soil.msu.ru/soilyeasts/genera/Ustilaginaies.htm
http://soil.msu.ru/soilyeasts/pics/PasteurEffect.htm
http://soil.msu.ru/soilyeasts/pics/PentosePCycle.htm
http://soil.msu.ru/soilyeasts/pics/BetaOxy.htm
http://soil.msu.ru/soilyeasts/ genera /Kluyveromices.htm
http://soil.msu.ru/soilyeasts/genera/Naumov.htm
ПРИЛОЖЕНИЯ
Приложения 1
КЛЮЧ ДЛЯ ОПРЕДЕЛЕНИЯ ВИДОВ РОДА SACCHAROMYCES (ПО В. И. КУДРЯВЦЕВУ)
1. При развитии в жидкой питательной среде организмы вызывают спиртовое брожение только моноз, глюкозы и галактозы - - - - - - - - - - - - - - - - - - - - - - - - - - - - - - - - - - - - - - - - - - - - - - - - - - - - - - Saccharomyces globosus,
2. Вызывают брожение глюкозы, фруктозы, а также сахарозы. - - - - - - - - - - - - - - - - - - - - - - - - - - - - - - - - - - - - - - - - - - - - - - - - - - - Saccharomyces ribis.
3. Вызывают брожение глюкозы, сахарозы и 1/>з> раффинозы:
а) галактозу сбраживают не всегда - - - - - - - - - - - - - - - - - - - - - - - - - - - - - - - - - - - - - - - - - - - - - - - - - - - - - - - - - - - - - - - - - - - Saccharomyces paradoxus;
б) галактозу сбраживают- - - - - - - - - - - - - - - - - - - - - - Saccharomyces сasel
4. Вызывают брожение глюкозы, галактозы, сахарозы, раффинозы (1/>З>) и лактозы- - - - - - - - - - - - - - - - - - - - - - - - - - - - - - - - - - - Saccharomyces lactis.
5. Вызывают брожение глюкозы, мальтозы, галактозы, сахарозы и 1/>З> раффинозы:
а) выделяются из плодово-ягодных соков. Фермент галактозимазы.принадлежит к колеблющимся- - - - - - - - Saccharomyces vini;
б) выделяются из кисломолочных продуктов. Галактозимаза принадлежит к стойким ферментам- - - - - - - - - - - - - - - - - - - - Saccharomyces cartilaginosus.
6. Вызывают брожение глюкозы, сахарозы, 1/>З> раффинозы, мaльтозы и простых декстринов, галактозы не всегда- - - - - - - - Saccharomyces сеrеvisiае.
7.Вызывают брожение глюкозы, галактозы, сахарозы и раффинозы полностью, включая и мелибиозу- - - - - - - - - - - - - - - - - - - - Sаcch. Coreanus.
8. Вызывают брожение глюкозы, галактозы, сахарозы, раффинозы, включая мелибиозу и мальтозу- - - - - - - - - - - - - - - - - - - - - - - - - - - - - Sacch. uvarum.
9. Вызывают брожение глюкозы, галактозы, сахарозы, раффинозы, включая мелибиозу, мальтозы и простых декстринов- - - - - - - - -Sacch. Carlsbergensis.
10. Вызывают брожение глюкозы, сахарозы, 1/>З> раффинозы (но не галактозы) - - - - - - - - - - - - - - - - - - - - - - - - - - - - - - - - - - - Sacch. Chevalieri.
11. Вызвают брожение глюкозы, сахарозы, 1/>3> рaффинозы и мальтозы (но не галактозы) - - - - - - - - - - - - - - - - - - - - - - - - - - - - - - - - - - - - - Sacch. Oviformis
12. Вызывают брожение глюкозы, сахарозы, 1/>3> раффинрзы, мальтозы и простых декстринов (но не галактозы) - - - - - - - - - - - - - - - - Sacch. Baynus.
13. Вызывают брожение только глюкозы, галактозы и мальтозы - - - - - - - - - - - - - - - - - - - - - - - - - - - - - - - - - - - - - - - - - - - - - - - - - - - - Sacch. Chodati.
14. Вызывают брожение только, глюкозы, сахарозы и мальтозы. - - - - - - - - - - - - - - - - - - - - - - - - - - - - - - - - - - - - - - - - - - - - - - - - Succh. Heterogenicus.
15. Вызывают брожение только глюкозы и сахарозы - - - - - - - - - - - - - - - - - - - - - - - - - - - - - - - - - - - - - - - - - - - - - - - - - - - - - - - - Sacch. aceir – sacchari.
16. Вызывают брожение только глюкозы и мальтозы - - - - - - - - - - - - - - - - - - - - - - - - - - - - - - - - - - - - - - - - - - - - - - - - - - - - - - - - - - - Sacch. Prostoserdovi
Приложения 2

Рис 2.Установка БИОЛУК-3Ш
Рис.3. Колонии дрожжей Saccharomyces сеrеvisiае.